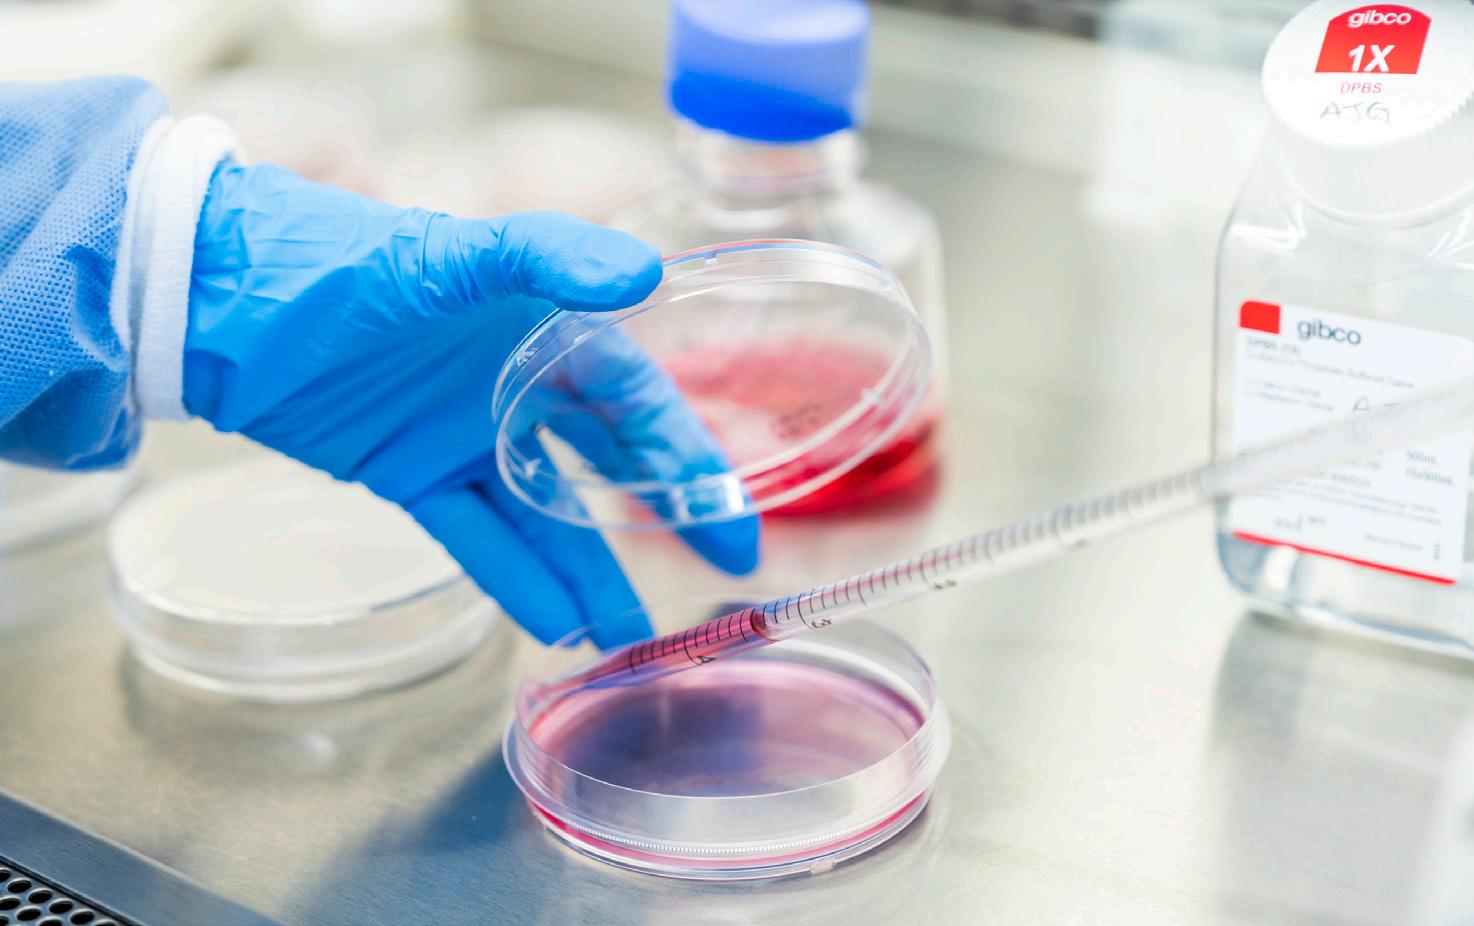

Beyond Summit THE
Reaching New Heights in Surgical Care

Message from the Chair

In the UCLA Department of Surgery, our purpose has long been our compass — steady through change, guiding us toward progress. Since our founding in 1955, that sense of purpose has united us across disciplines, divisions and generations. It continues to shape who we are and where we are going.
This year, we carried that purpose forward with renewed momentum. Beyond the Summit captures the spirit of a department that keeps climbing, even when the path is steep. We advanced in meaningful ways: building enduring programs, deepening the impact of our research and training the next generation of surgeons to lead with integrity and compassion. We launched and strengthened several initiatives that reflect our commitment to people and progress. The HEaL Trauma Program opened its doors, offering traumainformed care to survivors of violence through a model that integrates mental health support, case management and legal advocacy. At the Center for Advanced Surgical and Interventional Technology (CASIT), we continued to lead in surgical innovation,
advancing simulation, robotics and crossdisciplinary collaboration to shape the future of minimally invasive care.
Our research enterprise grew across divisions. Faculty led studies in trauma recovery, liver transplantation, AI-powered diagnostics, surgical education and more, securing NIH and other national funding in the process. These efforts speak to our focus on research that addresses urgent clinical needs and drives the field forward.
Education remained central to our mission. Our residents and fellows received national recognition, matched into competitive fellowships and stepped into leadership roles across the country. We expanded simulationbased learning and strengthened mentorship, reinforcing our commitment to developing surgical leaders who are both highly skilled and deeply human.
Clinically, we broadened access and enhanced care across a wide spectrum of services. The Liver Transplant Program sustained its national leadership, while teams in vascular, colorectal, trauma, endocrine and cardiac surgery pioneered new pathways to
improve coordination, outcomes and equity across UCLA Health.
Beyond the Summit captures the spirit of a department that keeps climbing, even when the path is steep.
Each of these milestones reflects our shared sense of purpose and our collective commitment to one another and to our patients. As we celebrate 70 years since our founding, we honor the progress behind us and look forward to the possibilities ahead. It is a privilege to work alongside individuals who care deeply, strive boldly and remind me that the summit is not our final stop — it is where we pause, reflect and set our sights even higher.
Sincerely,

O. Joe Hines, MD Chair, Department of Surgery
MISSION & VISION
Our Vision
To deliver equitable, innovative and world-renowned surgical care illuminated by discovery and compassion

The five-year strategic plan for the UCLA Department of Surgery defines who we are and provides a roadmap for what we want to become. Generating the plan codified our core values and highlighted four key areas that represent the foundation of our present and future excellence as a department:
Community:
Prioritize outreach to improve health equity and instill a servicebased mindset.
Education:
Emphasize mentorship to create better surgeons and health care leaders.
Faculty: Foster an environment that promotes personal and professional satisfaction.
Research:
Promote engagement in research and innovation to improve patient outcomes.
Achieving the plan’s goals requires that we share a common vision for the future. Our shared vision will capitalize on the individual and collective talent within each division to advance our mission and remain a national leader in surgical care.
Mission

The UCLA Department of Surgery leads with:
1
Pioneering patient care: Our surgeons provide preeminent clinical care for all in our community.
2
Impactful research: Directing leading-edge research ensures exceptional patient outcomes and innovative treatment.
3
Next-level education: Mentorship, teaching and diverse clinical experience support the next generation of surgeons and academic leaders.
Advancing Surgical Care in One of the Nation’s Most Diverse Cities
Inclusive excellence initiatives drive innovation, mentorship and patient-centered care
Los Angeles is a city of diverse, lived experiences, where cultures, languages and backgrounds both shape opportunities and create challenges in health care. As a leader in surgical innovation, the UCLA Department of Surgery is committed to excellence beyond technical expertise, providing compassionate care to the diverse communities that define our city.
At the core of this commitment is inclusive excellence, a set of guiding principles that shapes the department’s culture by fostering mentorship, advancing education and expanding equitable access to care. Inclusive excellence programs in our department are available to all faculty, trainees and staff and serve to improve the lived experience of all members of our surgical community.
“In a city as diverse as Los Angeles, our responsibility extends beyond the operating room,” says Juan Carlos Jimenez, MD, MBA, vice chair for inclusive excellence and vascular surgeon. “We are building a culture where every team member feels valued and every patient receives the highest standard of care.”
Key Initiatives in Inclusion, Access and Innovation
To cultivate an environment where surgeons thrive, the department prioritizes mentorship, professional growth and well-being for all. A formal mentorship program supports early-career surgeons, while expanded family leave and wellness initiatives provide essential long-term support. Through these efforts, the

department builds a supportive environment where surgeons of all backgrounds have the tools to thrive.
Within the Los Angeles community, UCLA Health is breaking down barriers to care.
Each year, more than 1,700 critically injured patients receive trauma-informed care at Ronald Reagan UCLA Medical Center. As a pilot site for the Healing, Empowering and Liberating (HEaL) Trauma Program, UCLA Health enhances post-discharge support with
PTSD screening, community health worker engagement and comprehensive follow-up care. Additionally, UCLA Health continues to prioritize outreach in under-resourced communities. These efforts include expanding vascular screenings in South Los Angeles and increasing surgical services at Martin Luther King Jr. Community Hospital.
Education and research also play a pivotal role in advancing surgical equity. Trauma surgeon Areti Tillou, MD, leads the High
“We are building a culture where every team member feels valued and every patient receives the highest standard of care.”

School Pre-Med Summer Scholars Program, inspiring students from diverse backgrounds to pursue careers in surgery. Catherine J. Juillard, MD, MPH, trauma surgeon, directs the Program for the Advancement of Surgical Equity (PASE), which investigates strategies to reduce global surgical disparities, including the role of government policy in national surgical planning.
Peyman Benharash, MD, cardiac surgeon, explores AI-driven solutions to improve surgical access and examines how social determinants impact patient outcomes.
“These efforts don’t just check a box,” explains Dr. Jimenez. “Advancing inclusive excellence requires innovative solutions from all angles. Together, they ensure that our department is a place where teams have support, and every patient receives the care they deserve.”
Juan Carlos Jimenez, MD, MBA, vice chair for inclusive excellence
2024–2025 Year in Numbers
14,635
112,103

DIVISIONS
2024–2025 Year in Numbers
Division of Cardiac Surgery
Division of General Surgery
Division of Liver and Pancreas Transplantation
FINANCIAL & INSTITUTIONAL IMPACT
$121,518,441
Total in Gifts and Endowments
NEW RESEARCH AWARDS FY25
$18,069,130
Total in New Research Funding
70
$8,481,654
Total in New NIH Funding
32

TOTAL RESEARCH FUNDING
$103M
Empowering Innovation and Groundbreaking Discovery
By streamlining grant processes, supporting faculty funding and fostering mentorship, the UCLA Department of Surgery makes research a central focus

Research is a cornerstone of academic medicine, driving discoveries that lead to new therapies and deeper insights into disease. These advances help refine treatment protocols and improve outcomes for patients. However, when paired with the more pressing daily rigors of academic medicine — clinical care and teaching — research is often viewed as a tertiary priority.
“If we think of academic medicine as a threelegged stool, the leg for research has often been shorter,” says Gerald S. Lipshutz, MD, vice chair for research and kidney and pancreas transplant surgeon. “Our goal as a department has been to make it easier for our faculty to perform research — to get that leg to the same length as the others — and to encourage our faculty to embrace a new perspective.”
To that end, a research committee led by Dr. Lipshutz and Karen Woo, MD, PhD, vascular surgeon, is spearheading initiatives to make research and grant submissions more efficient and successful. Due to the committee’s efforts, faculty members can now apply for core grants that provide start-up funds to generate preliminary data. These grants come with a commitment to submitting a full research proposal. For projects already in progress, department-funded bridge grants offer relief to faculty facing a gap in funding.
Karen Woo,
starting with research grants because they’re trackable,” Dr. Lipshutz says, “but it’s our hope to scale this academic RVU system to additional types of projects, depending on the success of the pilot.”
These efforts align with department leadership’s goal of becoming a national leader in surgical research. In recent years, the department has gained significant ground. There has been notable growth in sponsored research, with a 74% increase in proposals and a 100% increase in awarded dollars since 2021 (for a total of $24 million in 2024).
MD, PhD, Justine C. Lee, MD, PhD,
and Vatche G. Agopian, MD, were inducted into the American Surgical Association in recognition of their outstanding contributions to surgical science and education.
In addition, the department hired a grant writer in 2024 to assist faculty throughout the grant writing process. “I would say it is more of a grant ‘helper,’ as there are parts of the grant that only the researcher can truly convey,” Dr. Lipshutz says. “But the writer is there to ease the burden.” To address disparities in compensation, the department created an academic RVU to account for the time faculty spend on research, which often requires stepping away from clinical care. “We’re
Seven of the department’s eight divisions receive NIH funding, with the goal of all eight reaching that milestone this year through the strategic initiatives and additional hires. For these new hires, the department plans to offer start-up packages that include protected time dedicated to research. The committee is also investigating an expansion of mentorship programs, including those that lean into multidisciplinary relationships throughout the UCLA campus.
“We all need guidance, even our established faculty,” Dr. Lipshutz says. “Through mentorship and efficiency — and the gift of time — we’re creating solutions to make the research leg of the stool stronger across our department.”
Harnessing Data Science to Promote Equity in Injury and Surgery for Africa
UCLA Principal Investigator: Catherine J. Juillard, MD, MPH, trauma surgeon
Leveraging data science to reduce trauma and surgical disparities in Cameroon and Sub-Saharan Africa through SES surveillance, mHealth interventions and collaborative research.
AWARD:
$6.9 million from the National Institutes of Health

Validation and Translation of MasSpec Pen Technology for Intraoperative Evaluation of Non-Small Cell Lung Cancer
UCLA Principal Investigator: Bryan M. Burt, MD, division chief of thoracic surgery
Evaluating a novel proteomics platform for rapid (~8-second) intraoperative detection of lung cancer to improve surgical margin assessment.
AWARD:
$3 million from the National Cancer Institute
Association of BRAF V600E Allele Frequency with Clinicopathologic Outcomes in Papillary Thyroid Cancer
UCLA Principal Investigators: Masha Livhits, MD, endocrine surgeon, and Michael W. Yeh, MD, section chief of endocrine surgery
Investigating the prognostic significance of BRAF V600E allele frequency in papillary thyroid cancer and its association with aggressive pathologic features.
Gene Therapy for Creatine Deficiency Disorder (Guanidinoacetate Methyltransferase Deficiency)
UCLA Principal Investigator: Gerald S. Lipshutz, MD, vice chair for research and kidney and pancreas transplant surgeon
Developing a viral vector-based gene therapy to restore normal creatine levels and prevent complications associated with GAMT deficiency. Funding supports pre-IND preparation for FDA submission and initiation of a Phase 1 clinical trial.
AWARD:
$5.1 million from the California Institute for Regenerative Medicine
Causes and Consequences of Adenosine Signaling in Pancreatic Cancer
UCLA Principal Investigators: Timothy R. Donahue, MD, division chief of surgical oncology; Caius Radu, MD, scientist; Zev Wainberg, MD, gastrointestinal medical oncologist
Supporting a Phase 1/2 clinical trial combining chemoimmunotherapy for pancreatic cancer and funding laboratory studies on mechanisms of response and resistance.
AWARD:
$3.3 million from the National Cancer Institute
Improving the Patient Experience of Hemodialysis Vascular Access Decision-Making
UCLA Principal Investigator: Karen Woo, MD, PhD, vascular surgeon
Developing an interactive guide that incorporates prognostic models to aid patient engagement and decisionmaking regarding vascular access.
AWARD:
$1.5 million from the National Institute of Diabetes and Digestive and Kidney Diseases
Novel Peptide-Impregnated Hydrogel as a Wound Healing Device
UCLA Principal Investigators: Chia Soo, MD, plastic surgeon; Zhong Zheng, PhD, research scientist
Designing an innovative hydrogel to enhance wound healing by boosting tissue strength beyond traditional mechanical closure methods.
AWARD:
$505,000 (UCLA portion) from the National Institute of Dental and Craniofacial Research
Outcomes Following Implementation of a RiskBased Treatment Algorithm
for
Infants
with
Necrotizing Enterocolitis
and
Congenital Heart Disease
UCLA Principal Investigators: Justin Wagner, MD, pediatric surgeon; Jordan Rook, MD, general surgery resident

Evaluating an evidence-based algorithm that improves management of necrotizing enterocolitis in infants with congenital heart disease, reducing antibiotic use, imaging and NPO duration without increased complications.
AWARD:
$10,000 from the Little Giraffe Foundation
Computational Flow Dynamics Simulation and ECMO System Development for Battlefield Use
UCLA Principal Investigator: Peyman Benharash, MD, cardiac surgeon
Supporting the development of a portable ECMO system with a lowprofile cannula and anticoagulationfree pump/oxygenator for battlefield applications, managed through CASIT.
Learn more on page 52
AWARD:
$494,000 (Phase 1) from the Defense Advanced Research Projects Agency (DARPA)
Group 1 Innate Lymphoid Cells (ILCs) Protect Liver Transplants From IschemiaReperfusion Injury Via an Interferon GammaMediated Pathway
UCLA Principal Investigator: Jerzy Kupiec-Weglinski, MD, PhD, the Paul I. Terasaki Chair in Surgery at UCLA
Revealing a novel interferon gammamediated cytoprotective role of group 1 ILCs in liver transplantation.
AWARD:
$2.3 million from the National Institutes of Health
Mechanism and Function of CEACAM1 Splice Isoforms
UCLA Principal Investigator: Jerzy Kupiec-Weglinski, MD, PhD, the Paul I. Terasaki Chair in Surgery at UCLA

Elucidating the precise mechanisms by which CEACAM1 RNA splicing may be exploited to develop targeted interventions towards novel therapeutic strategies. More clinical studies are needed.
AWARD:
$9.7 million from the National Institutes of Health
QUALITY IMPROVEMENT
From Insight to Impact: Transforming Surgical Outcomes
Collaboration is the fuel behind a targeted initiative to reduce length of stay as well as achieve new national accreditations for quality and patient safety
Reducing hospital stays. Achieving national accreditations. Reshaping the future of surgical quality. These milestones are not just goals — they are the results of a strategic, data-driven approach to quality and patient safety at the UCLA Department of Surgery.
Leading this transformation is Marcia Russell, MD, vice chair for quality and safety and colon and rectal surgeon, who
spearheads multidisciplinary efforts to push beyond existing standards.
“The most successful quality improvement (QI) projects emerge from a shared vision and have a direct impact on patients,” Dr. Russell explains.
“Clinicians recognize where change is needed. Leadership must listen, harness that momentum and guide complex, system-wide improvements.”

Rethinking Recovery: A Smarter Approach to Shorter Hospital Stays
Surgical teams at UCLA Health are redefining what it means to recover faster. Reducing hospital stays requires more than efficiency; it demands rethinking protocols, leveraging data and ensuring that every patient fully benefits from the latest advancements in perioperative care. Dr. Russell is directing this effort, overseeing a division-led strategy that replaces a one-sizefits-all mandate with targeted, evidence-based solutions.
“We’re looking for efficiencies, redundancies and opportunities to modernize,” Dr. Russell shares. “Each division generates ideas. My strategy is to identify successes, refine
the details and scale the improvements for broader adaptation.”
The results speak for themselves with the following examples: First, thoracic surgery will be conducting a six-month trial using Exparel, a long-acting local anesthetic, to assess whether it provides pain control comparable to epidurals while also reducing hospital stays. Ultimately, the results of this trial may be applicable to other surgical specialties that rely on epidurals for postoperative pain control. Second, pediatric surgery has reduced length of stay by nine hours with a new nonoperative appendicitis protocol, speaking to the benefits of standardizing care. Meanwhile, surgical oncology and colorectal surgery are refining and standardizing enhanced recovery after surgery (ERAS) order sets for Whipple and colectomy, streamlining preoperative workflows for faster recovery. Other divisions may also leverage these workflows to implement ERAS pathways in the future.
National Recognition for Surgical Excellence
Through rigorous evaluation, collaboration and data-driven improvements, the department achieved prestigious designations from the American College of Surgeons (ACS).
For example, Ronald Reagan UCLA Medical Center earned recognition as an ACS National Surgical Quality Improvement Program (NSQIP) Meritorious Hospital. Additionally,
“The
most successful quality improvement projects emerge from a shared vision and have a direct impact on patients. Clinicians recognize where change is needed.
Leadership must listen, harness that momentum and guide complex, systemwide improvements .”

and safety
UCLA Mattel Children’s Hospital achieved Level 1 designation in the ACS Children’s Surgery Verification Program, making it the first pediatric surgery center in Los Angeles to hold this distinction.
“These are the result of years of focused, collaborative work,” says Dr. Russell. “They demonstrate our commitment to challenging outdated processes, breaking down silos, fostering open communication, tracking data, responding to feedback and pushing quality forward to not only meet standards, but establish new ones.”
These achievements reaffirm UCLA Health’s role as a leader in surgical excellence, continuously pushing the boundaries of patient care, safety and innovation.
Marcia Russell, MD, vice chair for quality
A Vision for the Future
UCLA Health’s surgical leadership advances through clinical operations and strategic planning

The UCLA Department of Surgery is globally recognized for its surgical excellence, a reputation built on innovation, expertise and an unwavering commitment to high-quality patient care. Maintaining that leadership requires continuous investment in strategy and clinical operations.
To support this vision, the department appointed Michael W. Yeh, MD, endocrine surgeon, as the vice chair for clinical operations and strategic planning in February 2025. In this role, Dr. Yeh drives initiatives to enhance patient care, optimize clinical workflows and advance strategic initiatives
in alignment with UCLA Health’s mission. He succeeds Andrew L. Da Lio, MD, chief of plastic and reconstructive surgery, whose unwavering commitment to surgical and clinical excellence left an enduring impact.
As section chief of endocrine surgery and medical director of the UCLA Health Endocrine Center, Dr. Yeh has a proven record of building strong programs. His leadership will be instrumental in further elevating UCLA Health’s national standing in surgical excellence.
AI Scribes to Reduce Surgeons’ Burden
In late 2024, Dr. Yeh facilitated a pilot program of AI-powered scribes to assist surgeons with
patient encounter documentation, allowing them to focus more on patient care. Based on the findings of the pilot program, UCLA Health has chosen to move forward with the Nabla Copilot generative AI tool.
“We want to make life easier for our surgeons , freeing them from administrative tasks so they can dedicate their time to the direct patient care and research that truly matters.”

Michael W. Yeh, MD,
vice chair for clinical operations and strategic planning
“This ambient listening technology extracts the essential clinical details from patient conversations, substantially reducing the time needed for documentation and potentially reducing physician burnout,” he says. “We want to make life easier for our surgeons, freeing them from administrative tasks so they can dedicate their time to the direct patient care and research that truly matters.”
As Dr. Yeh’s vision begins to take shape, his leadership will further strengthen UCLA Health’s position at the forefront of surgical excellence.
Division of Cardiac Surgery

Richard J. Shemin, MD
Division Chief

Abbas Ardehali, MD
Shyamasundar Balasubramanya, MD
Peyman Benharash, MD
Reshma M. Biniwale, MD, MS
Marineh Bojalian, MD
Peter Downey, MD
Murray H. Kwon, MD, MBA
Yas Sanaiha, MD
Ming-Sing Si, MD
Glen S. Van Arsdell, MD
FACULTY
Expanding Possibilities in Cardiac Surgery
Collaboration, innovation and technology fuel a higher standard of care
With an expanding patient volume and world-class expertise, the Division of Cardiac Surgery continues to scale new frontiers in cardiovascular treatment. The division’s 11 expert surgeons collectively perform over 1,700 open-heart cases annually, including approximately 300 pediatric and general heart procedures. These numbers place UCLA Health at the peak of regional and national cardiac centers. UCLA consistently achieves clinical outcomes that set the standard for excellence.
“We continue to lead in all aspects of cardiac surgery: pediatrics; transplantation
Shemin,
of both heart and lungs; thoracic aortic disease; valve surgery; and minimally invasive approaches, including roboticassisted procedures for mitral valve repair,” says Richard J. Shemin, MD, division chief and the Robert & Kelly Day Chair in Cardiothoracic Surgery.
In recognition of this excellence, UCLA Health received the Mitral Valve Repair Reference Center Award from the American Heart Association and the Mitral Foundation for the fourth consecutive year. Dr. Shemin, UCLA Health’s mitral reference surgeon, has personally performed more than 1,000 robotic mitral valve procedures, underscoring the

division’s leadership in the field. Additionally, the division has received recognition as a high performing participant in the American Heart Association’s Target Aortic Stenosis Initiative.
Elevating Cardiac Care with Advanced Facilities
In 2024, the division launched a stateof-the-art hybrid operating suite, built to seamlessly combine catheter-based interventions with open surgery in a single setting. This innovative facility eliminates the need for multiple hospital procedures, allowing for more efficient, patient-centered care.
“We’re already leveraging this space for complex thoracic aortic procedures,” Dr. Shemin explains. “By merging different
“We continue to lead in all aspects of cardiac surgery : pediatrics; transplantation of both heart and lungs; thoracic aortic disease; valve surgery; and minimally invasive approaches, including robotic-assisted procedures for mitral valve repair.”

Richard J. Shemin, MD, division chief and Robert & Kelly Day Chair in Cardiothoracic Surgery
techniques and specialties, we can optimize patient outcomes in one integrated approach.” This collaborative ethos extends to the multidisciplinary UCLA Health Aortic Center, where cardiac and vascular surgeons work in tandem to manage complex aortic disease. With the recent addition of a fourth aortic surgeon, the division is steadily expanding its capacity to treat complex cases, reinforcing UCLA’s position as a premier center for cardiovascular care.
Strengthening Pediatric Heart Care Through Collaboration
Strategic partnerships continue to drive innovation in pediatric cardiac care. Now in its third year, the alliance between UCLA Health and Children’s Hospital of Orange County (CHOC) is transforming the landscape for young patients with congenital heart disease. This shared program enhances access to specialized care, benefiting hundreds of children each year.
Through this collaboration, UCLA surgeons operate at CHOC, while CHOC’s team contributes at UCLA. This exchange strengthens both institutions by boosting case volume, improving outcomes, and enhancing national rankings in pediatric care. The partnership underscores UCLA’s dedication to extending care beyond its walls and expanding access. “We are committed to providing exceptional care, without exception,” Dr. Shemin reiterates.
Richard J.
MD, has been named the 2025 recipient of the Sherman M. Mellinkoff Faculty Award, the highest honor from the David Geffen School of Medicine, recognizing his outstanding contributions to surgery and patient care.
With more than 10,000 cardiac surgical procedures performed annually, UCLA Health continues to ascend toward more advanced, data-driven care. A major focus in 2024 was the adoption of artificial intelligence and predictive modeling to refine clinical decision-making.
Through a long-standing partnership with the University of California Cardiac Surgery Consortium led by Richard J. Shemin, MD, division chief and the Robert & Kelly Day Chair in Cardiothoracic Surgery, UCLA Health has studied 200 data points per patient over the past decade, allowing for highly precise predictions of surgical outcomes.
“By reviewing outcomes for aortic valve replacement, for instance, we can identify patients who have no complications and leave the hospital within five days,” Dr. Shemin says. “It’s invaluable for refining treatment protocols, improving efficiency and controlling costs.”
Telehealth and remote monitoring technologies are also transforming postsurgical care. Wi-Fi–enabled blood pressure cuffs, thermometers and pulse oximeters provide real-time data, allowing physicians to intervene promptly when necessary. This proactive approach reduces readmissions and ICU stays, ultimately improving patient well-being.
“By making timely adjustments to medications and addressing concerns early, we’re enhancing patient outcomes and ensuring a more sustainable approach to cardiac surgery,” Dr. Shemin adds.
DIVISION OF CARDIAC SURGERY
Technology at the Heart of Growth
Harnessing AI, predictive modeling and remote monitoring for better outcomes

Pioneering the Future of Cardiac Innovation
In 2024, Peyman Benharash, MD, was appointed executive director of UCLA Health’s Center for Advanced Surgical and Interventional Technology (CASIT), marking a pivotal step in the division’s commitment to in-house innovation. While industry partnerships remain critical, developing solutions internally allows for more targeted advancements tailored to specific patient needs. Under Dr. Benharash’s
leadership, CASIT is expanding its role in surgical innovation, ensuring that UCLA Health remains at the forefront of medical technology (page 52).
Investment in the next generation of surgical leaders also remains a priority. CASIT hosts an annual, hands-on course in cardiac and thoracic surgery, equipping residents from across the western United States with experience in robotic simulators. Simultaneously, the Cardiac Outcomes Research Laboratory
(CORELAB) continues to drive forward research, contributing more than 100 publications last year alone (page 17).
In collaboration with
The division’s heart and lung transplant programs, under the leadership of Abbas Ardehali, MD, remain high volume and pursue innovations in procurement of organs and in the treatment of end-stage heart and lung conditions, consistently achieving excellent outcomes. In 2024, UCLA performed 182 heart and lung transplants — the second-highest number in UCLA’s history — and both programs are on track to maintain these volumes in 2025. Multidisciplinary teams work to provide advanced circulatory and pulmonary support in addition to transplantation in both adult and pediatric patients. The program remains one of the most competitive in transplantation education, leading in presentations and symposiums.
By fostering a culture of collaboration and discovery, the Division of Cardiac Surgery continues its ascent beyond today’s challenges, shaping the future of cardiovascular care and setting new benchmarks in surgical excellence.
CASIT continues to drive innovation with robotic simulation technology.
CASIT, Peyman Benharash, MD, and Armin Alipour filed a patent for an AI-based tool to assess open surgical skills.
DIVISION OF CARDIAC SURGERY
CORELAB Paves New Pathways with Stellar Research Record
The laboratory continues to produce a wide range of published work that is leading to new and improved outcomes for patient care

Researchers at the Cardiac Outcomes Research Laboratory (CORELAB) published more than 100 papers in the past year. These studies deepen our understanding of how surgical processes and patient-specific factors, such as socioeconomic status, influence cardiovascular outcomes.
“Medicine has reached a crossroads where professionals have to decide whether to focus on clinical medicine or research,” says CORELAB Director Peyman Benharash, MD. “Our goal is to continue to support folks who want to do both, because that’s where our innovation and quality come from.”
Below is a snapshot of the lab’s notable research projects from this fiscal year.
ECMO on the Battlefield
Extracorporeal membrane oxygenation (ECMO) is a technique that supports patients with advanced cardiac and/or pulmonary failure. CORELAB conducts research examining the efficacy and outcomes of ECMO among national cohorts. This year, that work expanded into military settings, with funding from the Defense Advanced Research Projects Agency (DARPA) to examine the efficacy of ECMO on the battlefield.
“UCLA Health has one of the largest ECMO programs in the country,” Dr. Benharash
says. “The new platform would be portable and usable on the frontlines of a battlefield without a surgeon or large team present.”
Researching Disparities in Hospital Care
“UCLA Health has one of the largest ECMO programs in the country. The new platform would be portable and usable on the frontlines of a battlefield without a surgeon or large team present.”

Student researchers examined why patients from socioeconomically disadvantaged backgrounds experience worse surgical outcomes, focusing on systemic barriers and quality of care at lower-cost hospitals. They discovered a patient’s home environment significantly impacts outcomes, even after major inpatient surgeries like heart transplants. “This points to the fact that patients don’t just need to get to the phase of transplantation, but they need longitudinal care in protecting the organ from rejection and infection,” Dr. Benharash says. Through this research, the team developed the CORE score, a new model to predict postsurgical mortality in patients with chronic conditions. The researchers also investigated whether expensive hospitals provide better care. They discovered that surgeries at lower-cost hospitals tend to have fewer overall complications. The next step, says Dr. Benharash, is to study what makes these lower-cost hospitals effective and explore how their practices can achieve broader application.
Peyman Benharash, MD, CORELAB director
CORELAB researchers practice surgical techniques as a team.
Division of General Surgery
FACULTY

Raul J. Rosenthal, MD Division Chief
Adam A. Abiri, PhD
Megan L. Brenner, MD
Charles F. Chandler, MD
David C. Chen, MD
Yijun Chen, MD
Formosa Chen, MD, MPH
Robert A. Cherry, MD
Ariane Christie, MD
Henry M. Cryer III, MD
Guido Eibl, MD
Rory Geoghegan, PhD
Melinda Maggard-Gibbons, MD, MSHS
Sarah M. Gilyard, MD
Avital Harari, MD, MBA, MSc
O. Joe Hines, MD
Darryl T. Hiyama, MD
Catherine J. Juillard, MD, MPH
Kevork K. Kazanjian, MD
Clifford Ko, MD, MSHS
Mary R. Kwaan, MD, MPH
Catherine E. Lewis, MD
Anne Y. Lin, MD
Marsha Livhits, MD
Edward H. Livingston, MD
David Machado-Aranda, MD
Ian T. Macqueen, MD
Michael W. Robinson II, MD
Marcia McGory Russell, MD
Tara A. Russell, MD, PhD, MPH
Miklos Sahin-Toth, MD, PhD
Darin Saltzman, MD
Mark Sawicki, MD
Paul J. Schmit, MD
Eric R. Simms, MD
Eri Srivatsan, PhD
David Tichansky, MD, MBA
Areti Tillou, MD
James Wu, MD
Michael W. Yeh, MD
Kyle A. Zanocco, MD

Jonathan Hiatt, MD, Professor Emeritus
Howard Reber, MD, Distinguished Professor of Surgery Emeritus
DIVISION OF GENERAL SURGERY
Advancing Surgical Frontiers with Purpose and Precision
At the Division of General Surgery, no surgical challenge is too routine — or too complex. The division brings an unmatched depth of expertise to every case, earning a global reputation as one of the premier surgical programs. Under the direction of Raul Rosenthal, MD, who joined as division chief in June 2025, the team continues to refine established techniques, develop novel approaches and advance patient care.
“One of my top priorities is to create a collaborative division focused on quality improvement and shared success,” Dr. Rosenthal says.
This year, the division expanded its minimally invasive and robotic surgery programs, extended services to additional UCLA Health facilities and earned meritorious recognition from the American College of Surgeons (ACS) National Quality Improvement Program (NSQIP). The ACS awards this honor to only the top 12% of eligible hospitals for excellence in both standard and high-risk cases.
Reinforcing its commitment to surgical innovation, the division welcomed Bijan Najafi, PhD, as professor of surgery and research director at the Center for Advanced Surgical and Interventional Technology (CASIT). A leader in medical devices and digital health, Dr. Najafi brings a forward-thinking vision for advancing care beyond hospital walls.
Dr. Rosenthal sees CASIT as a critical platform for innovation. To that end, he will be launching a new initiative within the center: fluorescence image-guided surgery,

which enhances visualization during surgery, improving safety across specialties including neurosurgery, gastroenterology and cardiac surgery.
Aligned with Dr. Rosenthal’s vision and the division’s broader mission, each general surgery section continues to push boundaries across surgical care, research and education. Explore recent highlights from each section.
Bariatric Surgery
The Bariatric Surgery team continues to raise the bar in patient care, consitently surpassing national benchmarks in patient care. With a patient satisfaction rate exceeding 95%, the team outperforms national standards in several key metrics, performing 50% fewer revision operations and shortening hospital stays by an average of 24 hours.
Further enhancing the team’s expertise,
the division recently welcomed Eric R. Simms, MD, a skilled minimally invasive surgeon and accomplished researcher. This commitment to excellence has earned the team a compelling reputation and enduring patient loyalty, with one-third of new patients referred by former ones.
At the same time, the national rise in availability of weight-loss medications has led to a decline in demand for bariatric surgery. In response, the team (continued on next page)
Darryl Hiyama, MD, won the David Geffen School of Medicine
2025 Serge & Yvette Dadone Clinical Teaching Award.
The Division of General Surgery is driving surgical innovation, improving access and shaping national standards of care
Bijan Najafi, PhD, at the Center for Advanced Surgical and Interventional Technology (CASIT)
DIVISION OF GENERAL SURGERY
Advancing Surgical Frontiers with Purpose and Precision
(Continued)
developed a novel approach, combining gastric sleeve surgery with weight-loss medications to help patients achieve long-lasting results.
“The preliminary data looks very promising,” says Yijun Chen, MD, section chief of bariatric surgery. “Many patients are reaching their goal weight faster with this protocol.”
Colon and Rectal Surgery
With internationally recognized faculty at the helm, the Colon and Rectal Surgery section conducts groundbreaking research, provides evidence-based care and trains surgical leaders. Known for expertise in robotic and complex colorectal procedures, the team also plays a key role in systemwide quality improvement initiatives, including efforts to reduce postoperative infections across UCLA Health.
This year, the section made significant advancements in enhancing the surgical care of older adults. Clifford Ko, MD, section chief of colon and rectal surgery, and Marcia Russell, MD, developed the first CMS Performance Measure for geriatric surgical care, focusing on delirium prevention, frailty assessment and shared decision-making. Implemented on Jan. 1, 2025, this measure aims to improve surgical outcomes for elderly patients.
Drs. Ko and Russell also published a study in the American Journal of Surgery highlighting geriatric-specific risk factors and the importance of preoperative vulnerability screening.

“For many older adults, quality of life means being at home, not in a hospital,” Dr. Ko explains. “We’re evaluating how often that happens and how we can improve it, including through prehabilitation.”
Building on these efforts, Tara Russell, MD, is driving innovation in rectal cancer care. Her research focuses on minimizing surgical intervention and ostomy use through a watch-and-wait approach — a strategy with the potential to preserve organ function and improve long-term quality of life. This year, she received
a seed grant from the UCLA Jonsson Comprehensive Cancer Center to investigate barriers to implementing this approach in clinical practice.
Endocrine Surgery
UCLA’s Endocrine Surgery section is internationally recognized for its innovative research and exceptional clinical outcomes, performing over 1,200 major operations annually. In December 2024, the team set a record by completing 14 adrenalectomies in a single month.
Through leading-edge research, the Endocrine Surgery team advances personalized treatment for thyroid cancer. Masha Livhits, MD, director of the endocrine surgery fellowship, leads molecular testing studies to refine precision treatment strategies. Building on this work, resident Max Schumm, MD, published research identifying genetic variations linked to papillary thyroid cancer, further supporting the move toward genomically informed care.
“Ten years ago, we treated all thyroid cancers the same,” says Michael W. Yeh, MD, section chief of endocrine surgery. “Now, we can individualize treatment based on genetics.”
As renowned authorities in thyroid cancer, Dr. Yeh and Dr. Livhits help shape national standards of care — Dr. Livhits through contributions to the National Comprehensive Cancer Network guidelines and Dr. Yeh as a member of the American Thyroid Association guidelines task force. “Because of our research, we’re asked to serve on these committees,” Dr. Yeh says. “We create new knowledge that informs care, not just here at UCLA, but across the nation.”
In support of the section’s academic mission, the team secured a $100,000 donation from Omaze in 2024 to advance research initiatives. Additionally, James Wu, MD, was inducted into the American College of Surgeons Academy of Master Surgeon Educators, reflecting UCLA’s continued leadership in surgical education and mentorship. (continued on next page)
DIVISION OF GENERAL SURGERY
Advancing Surgical Frontiers with Purpose and Precision
(Continued)

Gastrointestinal Surgery
David C. Chen, MD, professor of clinical surgery, is an international expert in complex hernia repair with a clinical and research emphasis on postoperative chronic pain. Dr. Chen also travels to Haiti to teach local surgeons how to perform repairs for advanced hernias, a leading cause of disability. Through his program, he helps build surgical capacity by training local providers to perform these procedures safely and effectively.
Trauma Surgery
The Trauma Surgery team provides lifesaving care for the most complex and
critical cases in Southern California.
Leveraging surgical expertise and a worldclass health system, the team consistently achieves outcomes that few centers can match.
In response to a marked increase in patient volume, the Trauma Surgery section expanded its capacity. Two nurse practitioners recently joined the team, reinforcing its ability to deliver timely, high-quality care without compromising outcomes.
quality improvement program for emergency surgery. This includes the development of a dedicated registry to monitor complications, enabling data-driven improvements in trauma care delivery.
A study led by Areti Tillou, MD, found that 25% of hospitalized e-scooter injury patients were under the influence, highlighting the need for safety policies and prevention.
To address the broader needs of trauma patients, the Department of Surgery and UCLA Health launched the UCLA HEaL Trauma Program, a comprehensive outpatient trauma clinic, under the leadership of Catherine J. Juillard, MD, MPH (page 58).
Welcoming Raul Rosenthal, MD, as Division Chief

Megan L. Brenner, MD,
was inducted into the American College of Surgeons Academy of Master Surgeon Educators and continues to serve as a member of the ACS National Committee on Trauma.
Driven by a deep commitment to surgical excellence, the team implemented a robust
Advances in resuscitation and hemorrhage control continue to be led by Megan L. Brenner, MD, including the expansion of a multidisciplinary clinical team to improve outcomes for patients with placental hemorrhage. She has co-authored over 160 peer-reviewed papers supported by grants from the Department of Defense, which are the first published clinical algorithms and outcomes from use of REBOA for trauma as well as postpartum hemorrhage. She created and continues to chair the ACS Committee on Traumas Basic Endovascular Skills for Trauma (BEST) Course and has expanded it to 18 course sites nationally and internationally.
Dr. Rosenthal’s surgical expertise includes conditions of the foregut as well as minimally invasive and bariatric surgery. He completed residencies in his native Argentina, Germany and the United States and established one of the largest minimally invasive and bariatric surgery training programs in the United States. At UCLA, his immediate priorities include:
• Enhancing quality improvement initiatives and standardized care pathways.
• Securing new grant funding from foundations and industry.
• Increasing faculty-trainee interaction.
• Expanding clinical programs in colorectal, GI and fluorescence imageguided surgery.
• Developing a dedicated section of minimally invasive foregut surgery.
Division of Liver and Pancreas Transplantation
FACULTY

Douglas G. Farmer, MD
Division Chief
Gina Choi, MD
Mohamed M. El Kabany, MD
Steven-Huy B. Han, MD
Sentia Iriana, MD, MS
Vatche G. Agopian, MD
Samer S. Ebaid, MD, PhD, MS
Haofeng Ji, MD
Fady M. Kaldas, MD
Jerzy W. Kupiec-Weglinski, MD, PhD
Gerald S. Lipshutz, MD

Ronald Busuttil, MD, PhD, Professor Emeritus
Transplant Hepatology
Sammy Saab, MD, MPH
Akshay Shetty, MD
Jasleen Singh, MD
DIVISION OF LIVER AND PANCREAS
Redefining What’s Possible in Transplantation
Setting the standard for transplant surgery through trailblazing technology and consistent collaboration
UCLA is one of the only health systems in the world to offer liver, pancreas, intestine and multivisceral transplants for both children and adults. Surgeons in the Division of Liver and Pancreas Transplantation are supported by decades of transplant innovation at UCLA. This expertise enables whole, split and multiorgan transplants using the latest technology, says Douglas G. Farmer, MD, division chief.
“Our leadership is extremely supportive of transplant programs,” Dr. Farmer says, “and our focus remains on raising the bar through innovation, research and a perpetual focus on collaboration.”
“Widespread acceptance, from both OPOs and patients, makes it [machine perfusion] a technology that’s easier to access and use for appropriate indications. The exciting part is there are more and more options are coming online. Competitive market forces will drive costs down, which allows us to offer this option to more patients.”
After a rigorous national search, Dr. Farmer was appointed division chief effective October 1, 2024. With more than two decades of service in the Department of Surgery, he brings exceptional academic, clinical and leadership expertise to advance liver and pancreas transplantation at UCLA. Dr. Farmer draws on (continued on next page)

TRANSPLANTATION
DIVISION OF LIVER AND PANCREAS TRANSPLANTATION
Redefining What’s Possible in Transplantation
(Continued)
deep experience across adult and pediatric liver transplants; intestinal and multivisceral transplants; and complex liver and GI surgery. Under his leadership, the division is entering a new era of innovation and excellence.
Expanding Access Through Normothermic Perfusion
The advent of normothermic machine perfusion revolutionized transplantation at UCLA Health, expanding the potential organ donor pool and allowing surgeons to perform more, and safer, transplants.
State-of-the-art perfusion machines preserve and recondition organs, turning traditionally high-risk livers into a viable option. UCLA Health’s liver transplant outcomes have remained among the best in the nation since the institution’s first machine perfusion transplant in 2022. The group can now use machine perfusion to prevent ischemic cholangiopathy in the transplanted liver. This breakthrough allows donated organs to remain viable for longer periods of time.
“Widespread acceptance, from both OPOs and patients, makes it a technology that’s easier to access and use for appropriate indications,” Dr. Farmer says. “The exciting part is there are more and more options are coming online. Competitive market forces will drive costs down, which allows us to offer this option to more patients.”
In 2024, UCLA performed 178 liver, three pancreas and four intestine transplants, more than any other center in the region. Almost one-third of the liver transplants

involved machine perfusion, and the number is growing rapidly.
Uniting Expertise Through Leadership
The division is committed to strengthening collaboration across UCLA’s diverse and successful transplant programs. The newly formed UCLA Health Transplant Council includes surgical and medical experts from UCLA’s heart, lung and kidney transplant
programs, with more members expected to join. The council meets six times a year to discuss major multidisciplinary research initiatives and innovative technologies at UCLA.
Ronald Busuttil, MD, PhD, was awarded the 2024 Medawar Prize by The Transplantation Society for transforming the field of liver transplantation.
“We have a growth mindset,” says Abbas Ardehali, MD, vice chair for transplantation and cardiothoracic surgeon. Dr. Ardehali collaborates with his liver,
pancreas, intestine and multivisceral transplant colleagues as part of the council. “We are striving to leverage our strengths in many dimensions of organ transplantation across all organs and to develop an integrated system to advance the field of transplantation, train the next generation of leaders and provide the best patient care possible.”
DIVISION OF LIVER AND PANCREAS TRANSPLANTATION
Keeping Research at the Core
From real-time organ monitoring to genetic therapies, the division’s translational research is redefining transplant science


New Liver Research Center Brings Expertise Together
The Comprehensive Liver Research Center at UCLA opened in 2024, ushering in a new era of liver disease research. The center brings together a collaborative group of clinicians and researchers who share resources, expertise and funding to drive innovation and discovery across the UCLA ecosystem.
Currently, the center is establishing a comprehensive platform for addressing metabolic dysfunction–associated steatotic liver disease (MASLD), which affects more than 100 million U.S. adults. “It tends to be a silent killer, because it often produces few or no early symptoms,” says Vatche G. Agopian, MD, director of the Dumont-UCLA Liver Cancer Center.
Researchers hope to increase awareness of MASLD’s impact among the communities of Los Angeles County. This outreach will be supported by the center’s extensive network, which includes 65 NIH-funded researchers and clinicians — among them, several UCLA community investigators. The team looks forward to expanding this network even further.
Reperfusion Monitoring
Jerzy Kupiec-Weglinski, MD, PhD, the Paul I. Terasaki Chair in Surgery at UCLA, is widely acclaimed for his expertise in deciphering mechanisms of ischemic reperfusion injury. Through a collaborative initiative with Fady Kaldas, MD, the team analyzes tissue and blood samples from livers undergoing transplantation, monitoring ischemic reperfusion injury in real time. Additional researchers in the division are redefining the reperfusion paradigm by examining the molecular effects of machine perfusion on donor livers.
Based on their findings, clinical trials are underway at UCLA to investigate how existing medications might be employed to make organs undergoing reperfusion even safer for recipients.
New Strategies for Liver Disorders
Translational research by Dr. Agopian is expanding the use of liquid biopsies in liver cancer — one of the most common indications for liver transplantation. This noninvasive approach is enabling earlier diagnosis and intervention, with the potential to significantly improve patient outcomes.
Gerald S. Lipshutz, MD, is exploring how genetic liver disorders might be treated using stem cells or gene-editing technology, potentially eliminating the need for solid organ transplantation and expanding therapeutic options for patients.
Fady Kaldas, MD, was elected as councilor to the American Board of Surgery.
Vatche G. Agopian, MD (left), and Rajat Singh, MD, MBBS, directors of the Comprehensive Liver Research Center at UCLA
Division of Pediatric Surgery


Shant Shekherdimian, MD Interim Division Chief
FACULTY
Daniel A. DeUgarte, MD
Howard C. Jen, MD, MS
Veronica Fair Sullins, MD
Justin P. Wagner, MD
DIVISION OF PEDIATRIC SURGERY
Pediatric Surgery Receives Top National Accreditation
This recognition, fueled by excellence in process and care, accelerates the division to leadership on a national scale
UCLA’s Division of Pediatric Surgery offers leading-edge care to infants and children across the region. The division serves the entire Los Angeles County DHS system for pediatric surgical needs, leads San Fernando Valley’s only pediatric trauma program and provides pediatric surgical care to more than 10 area NICUs.
The division aims to make the surgical experience as stress-free as possible for children and families. Across 11 hospitals and eight outpatient clinics, the team employs state-of-the-art techniques to shorten hospital stays and enhance recovery. To further streamline care, the division’s new patient navigator coordinates each patient’s personalized experience. The division also enhanced its capacity to care for an expanding list of conditions, launching research-based specialty clinics for bowel management, chest wall deformities, bariatric surgery and fetal care.
National Recognition Elevates Care for Children
The division received the highest ACS accreditation possible and is now a Level I Children’s Surgery Center.
“There’s a lot to be proud of in terms of the amount of effort and work that went into the verification, and the fact that we’re the first pediatric surgery center in Southern California to have this designation,” says Shant Shekherdimian, MD, MPH, interim division chief.
Daniel A. DeUgarte, MD, and resident Jordan Rook, MD, published a landmark study on meconium-related obstruction, earning an invited presentation at the 2025 Academic Surgical Congress.
The ACS verification positions the division as a national leader in pediatric surgery. Earning verification required the division to have exceptional infrastructure, capacity, technology and processes to ensure quality of care. Faculty formed special committees, implemented performance improvement initiatives and developed plans to continuously improve these programs.
emergency department, needed special carveouts for pediatric care. Pediatric surgeon Howard C. Jen, MD, MS, and pediatric anesthesiologist Ihab A. Ayad, MD, co-led the verification at UCLA Health.
“The processes that we put into place
and have subsequently built upon yield some of the highest returns on investment in terms of improving the care provided to children,” Dr. Shekherdimian says. “The ACS verification motivated us to have much more robust quality improvement processes.”
Last fall, the Division of Pediatric Surgery earned top accreditation through the American College of Surgeons (ACS) Children’s Surgery Verification Quality Improvement Program. This major milestone required the division to meet 104 rigorous standards aimed at elevating the quality of pediatric surgical care nationwide.
As one example, the multidisciplinary Pediatric Improvement and Patient Safety (PIPS) Committee is comprised of nurses, anesthesiologists, surgeons, quality improvement specialists and patient safety advocates. The team monitors outcomes and develops appropriate protocols and staff educational tools.
A Multidisciplinary Effort Achieves Results
Earning verification took years of planning, supported by investments at all levels of UCLA Health. Several groups, including the

DIVISION OF PEDIATRIC SURGERY
Elevating the Pectus Patient Experience
Less-invasive techniques, new research and a fast-track protocol allow patients to receive more personalized care
The Division of Pediatric Surgery’s long-standing pectus program continues to be a destination center, providing top-quality care to infants and young patients with chest wall deformities. The past year ushered in a shift to less-invasive approaches to pectus excavatum repair. The program remains one of the few centers that offers an
alternative to the Nuss procedure, employing vacuum bell technology when possible.
In 2024, the team published six years of quality improvement data from patients receiving pectus excavatum repair, showing the benefits of protocolized pain management and intercostal nerve cryoablation. The division’s enhanced recovery after surgery

(ERAS) protocol successfully reduced the need for discharge narcotics by 83%.
Traditionally, children will stay in the hospital for three to seven days after chest wall surgery. Now, the fast-track protocol discharges young patients within 24 hours after surgery. Patients with associated cardiac anomalies are co-managed through a new collaboration with UCLA Health cardiothoracic surgeons.
Creating Pathways to Faster Recovery for All Patients
Other newly implemented ERAS protocols address pain management, congenital hyperinsulinism, intussusception and appendicitis. For example, the division pioneered a nonoperative appendicitis pathway, using antibiotics alone to manage patients. Now, more than half of UCLA Health’s appendicitis patients (53%) choose this option, and costs have decreased as a result.
“We’ve published several papers showing the safety and efficacy of this cost-saving approach in the pediatric population,” Dr. Shekherdimian says. “Now we are pushing the envelope to study whether we can give antibiotics in the emergency department and send appendicitis patients home without any admission whatsoever, while maintaining our excellent outcomes.”
Reaching Beyond Our Walls

The division’s regional presence includes 24/7 pediatric surgical coverage to outlying highvolume pediatric hospitals and community clinics, providing care for children regardless of insurance status.
“The pediatric surgical care for all patients who fall into safety net programs is provided by our surgeons,” Dr. Shekherdimian says. “This is very rewarding work, as we believe all children should be entitled to highquality pediatric surgical care.”
In addition, UCLA’s pediatric surgeons have long-standing international relationships, developing quality improvement infrastructure alongside local nonprofits and government health organizations to enable high-impact surgeries and stronger health systems in Armenia, Mozambique, Nigeria and other countries across the globe (page 59).
DIVISION OF PEDIATRIC SURGERY
Additional Clinical and Research Highlights
A look at how our pediatric surgeons are advancing the field, at UCLA and beyond
Successful Protocol Delivers Surgical Milestone
In February 2025, Veronica Fair Sullins, MD, and Daniel A. DeUgarte, MD, performed the first successful congenital diaphragmatic hernia (CDH) repair while on ECMO under a new bivalirudin anticoagulation protocol in the neonatal ICU. Over the past year, a multidisciplinary team led by Howard C. Jen, MD, MS, and Meena Garg, MD, a neonatologist, refined this protocol. Thanks to the timely care provided by neonatology, patient transport, perfusion and pediatric surgery, the team achieved a successful ECMO cannulation, CDH repair and decannulation.

Daniel A. DeUgarte, MD
Dr. DeUgarte participates in UCLA Health’s fetal and ex-utero intrapartum surgery programs. He is currently investigating nonoperative management of appendicitis.


Veronica Fair Sullins, MD
Dr. Sullins, codirector of the division’s pectus clinic, serves as the Department of Surgery’s wellness officer. She represents UCLA through her involvement in the American Pediatric Surgical Association and the Musculoskeletal Multidisciplinary Tumor Board.

Justin Wagner, MD
Dr. Wagner is currently researching necrotizing enterocolitis in patients with cardiac malformations. His other research interests are in surgical education and training; he represents UCLA as a member of the Association for Surgical Education.

Christine Dichter, NP
The division’s nurse practitioner has taken on an expanded role, participating in quality improvement initiatives; coordinating care for complex patients particularly within the bowel management and pectus specialty clinics; and serving as a liaison for the division to multiinstitutional studies and registries.

C.
Dr. Jen is currently the medical director of children’s surgery for UCLA Mattel Children’s Hospital. His research leverages the surgical quality initiatives of the health system to improve care for pediatric surgery patients ranging from appendicitis to congenital diaphragmatic hernia.
Howard
Jen, MD, MS
Division of Plastic and Reconstructive Surgery

Andrew L. Da Lio, MD Division Chief
Kodi K. Azari, MD
Prosper Benhaim, MD
Brian Boyd, MD
Christopher A. Crisera, MD
Michael R. DeLong, MD
Nicholas Do, MD

Jaco H. Festekjian, MD
Mytien Goldberg, MD
Reza Jarrahy, MD
Justine C. Lee, MD, PhD
Edward H. Nahabet, MD
Wayne Ozaki, MD, DDS
Jason Roostaeian, MD
George H. Rudkin, MD
Timothy Schaub, MD
Ginger C. Slack, MD
Chia Soo, MD
Charles Y. Tseng, MD
Andrew J. Vardanian, MD
James P. Watson, MD
FACULTY
DIVISION OF PLASTIC AND RECONSTRUCTIVE SURGERY
National Leaders in Complex Reconstructive Care
Surgeons advance microsurgery, craniofacial reconstruction, gender-affirming care and hand surgery as they train the next generation of plastic surgeons

Under the leadership of Andrew L. Da Lio, MD, division chief, UCLA’s Division of Plastic and Reconstructive Surgery continues to deliver outstanding outcomes, expand access to care and provide cuttingedge surgical training. The highlights below display the division’s recent achievements.
Excellence in Microsurgery, Nerve Repair and Craniofacial Care
The Microsurgery Program, led by Christopher Crisera, MD, is a national authority in complex reconstruction for patients recovering from cancer, trauma and limb salvage procedures. Plastic surgeons specialize in autologous tissue transfer for head and neck, breast and extremity reconstruction. Nicholas Do, MD, earned the “Best Save Award” from the American Society for Reconstructive Microsurgery, underscoring the program’s expansive impact.
Complementing this work, Michael DeLong, MD, expanded the use of targeted muscle reinnervation and regenerative peripheral nerve interfaces. These techniques improve limb function and reduce pain in patients with amputations or traumatic injuries, reinforcing the division’s reputation in complex nerve reconstruction.
Supported by decades of experience, Wayne Ozaki, MD, DDS, leads the Craniofacial Surgery Program, which treats congenital and skeletal anomalies. In response to rising demand, the program expanded services to include reconstruction (continued on next page)
Researchers work in the laboratory of Justine C. Lee, MD, PhD, at UCLA.
DIVISION OF PLASTIC AND RECONSTRUCTIVE SURGERY
National Leaders in Complex Reconstructive Care
(Continued)
of complex skeletal deformities such as benign orthognathic tumors. The Cleft Lip and Palate Surgery Program also continued to grow, uniting multidisciplinary specialists to deliver compassionate care for children. Parallel efforts in lymphatic reconstruction gained momentum. Under the direction of Ginger C. Slack, MD, the Lymphatic Reconstruction team integrates vascularized lymph node transfer and lymphovenous bypass into breast reconstruction. This approach reduces lymphedema and improves long-term recovery.
Preparing Future Leaders in Reconstructive Surgery
The division combines clinical excellence with a strong commitment to education. Its Plastic and Reconstructive Surgery Residency
Plastic surgery residents gain firsthand experience in anatomic dissection, fracture repair and microsurgical techniques, developing both technical skill and clinical judgment .
Program prepares future surgeons to meet the highest standards of surgical practice. George Rudkin, MD, serves as program director, with curriculum co-directors Edward Nahabet, MD, and Nicholas Do, MD, providing key support. Plastic surgery residents gain firsthand experience in anatomic dissection, fracture repair and microsurgical techniques, developing both technical skill and clinical judgment. One of the program’s signature initiatives, the Intern Bootcamp, equips

Establishing a Dedicated Burn Center at West Valley Medical Center

As the division strengthens its regional footprint, burn care emerged as a key area for expansion. In February 2025, UCLA Health opened a new Regional Burn Center at West Valley Medical Center, extending access to high-level burn treatment for both adult and pediatric patients.
Led by Los Angeles native Andrew Vardanian, MD, the new center provides urgent and longterm care for burn injuries, including surgical reconstruction, hyperbaric oxygen therapy and dedicated rehabilitation services. Recovery pathways integrate psychological counseling, ensuring comprehensive support for burn survivors.
“Our burn center is one of the most distinctive in the Los Angeles area, offering the highest level of available burn care,”
Dr. Vardanian says. “We are so grateful to be able to expand our services to other areas of the community so that all patients have the same access to UCLA Health’s quality care.”
new trainees with core clinical skills through structured mentorship and immersive learning. The division also provides subspecialty training through the Facial Gender-Affirming Surgery Fellowship Program led by Justine C. Lee, MD, PhD — the first of its kind in the nation.
Additionally, the division hosted an advanced facial rejuvenation course through the UCLA Center for Continuing Professional Development. In collaboration with dermatology and ophthalmology faculty, the course offered practical training in surgical and nonsurgical techniques to surgeons nationwide.
DIVISION OF PLASTIC AND RECONSTRUCTIVE SURGERY
Advancing Research in Gender-Affirming Care, Prehabilitation and Breast Reconstruction
Faculty research is advancing reconstructive care — improving outcomes, access and regenerative solutions
The division’s commitment to advancing surgical care extends beyond the operating room. Faculty lead clinical, translational and basic science research across all major subspecialties, with 57 peer-reviewed publications produced this year alone. By fostering a collaborative culture, the division sets new benchmarks for excellence in reconstructive research.
Justine C. Lee, MD, PhD, serves as a driving force behind research in genderaffirming facial surgery. In partnership with the UCLA Gender Health Program and the Williams Institute, her team addresses clinical outcomes and systemic barriers to care.
“This is a pivotal time for gender-affirming surgeries, and we want to ensure we’re keeping the lines of access open with patients who need care,” Dr. Lee says. “In a state review of Medicaid policies published this year, we found there is often a lack of clarity around the types of care covered by Medicaid. We hope our partnership with the Williams Institute will continue to improve patient education.”
1 of 4
Dr. Lee is one of four UCLA faculty members selected among nearly 400 national recipients. Her achievement highlights the impact of interdisciplinary research and reflects her visionary leadership.
Dr. Lee also leads groundbreaking studies in psychological prehabilitation, showing that interventions such as

cognitive behavioral therapy can reduce pain, anxiety and hospital length of stay. These findings highlight the value of integrating mental health care into surgical pathways. Similarly focused on improving patient outcomes, Michael DeLong, MD, is developing a national surgical outcomes database focused on breast reconstruction. By capturing data across institutions, the initiative seeks to optimize decision-making and improve long-term outcomes for patients nationwide.
A New Drug for Tissue Repair
Chia Soo, MD, and her team identified a new mechanism by which fibromodulin — a protein involved in tissue repair — triggers cell death in myofibroblasts through interleukin 1 signaling. This process plays a key role in controlling excessive scar tissues. Their findings, published in Nature Communications, open new possibilities for treating keloids and hypertrophic scars. With the support from UCLA, the team developed a fibromodulinbased peptide drug, now in clinical trials. Early results are promising, with reduced scarring reported in 54 patients to date.
Justine C. Lee, MD, PhD, Honored with Presidential Early Career Award

Justine C. Lee, MD, PhD, earned the Presidential Early Career Award for Scientists and Engineers (PECASE), the highest honor bestowed by the U.S. government for early-career researchers. Presented under the Biden Administration, the award acknowledges her exceptional work in regenerative medicine and craniofacial research, as well as her leadership as a scientist and surgeon.
With a background in cell biology, Dr. Lee develops regenerative materials that instruct cells to rebuild bone when implanted into skull defects. This research aims to improve outcomes for patients with head and neck deformities caused by trauma or cancer, marking a major step forward in reconstructive science.
“This is an enormous honor, and completely unexpected,” Dr. Lee says. “I’m so proud of the work we’re doing that will ultimately help improve patient care outcomes.”
Justine Lee, MD, PhD (right), works with a researcher in her laboratory at UCLA.
Division of Surgical Oncology
FACULTY

Timothy R. Donahue, MD Division Chief
Begonya Comin-Anduix, PhD
Jennifer Baker, MD
Joseph G. Crompton, MD, PhD
James S. Economou, MD, PhD
Mark D. Girgis, MD
Farnaz Haji, DO, MS
Brian E. Kadera, MD
Nimmi Kapoor, MD
Jonathan C. King, MD
Amy M. Kusske, MD
Jason Link, PhD
Manuel Penichet, MD, PhD
Cristina Puig-Saus, PhD
Antoni Ribas, MD
Gregory M. Senofsky, MD
Mediget Teshome, MD, MPH
Carlie Thompson, MD
James S. Tomlinson, MD, PhD
Tracy Wells, PhD

Helena Chang, MD, Professor Emeritus
Frederick R. Eilber, MD, Professor Emeritus
With expanded clinical trials and unprecedented research funding, the Division of Surgical Oncology is redefining the future of cancer care. In 2024, the division secured $14 million from public grants, NIH awards, industry support and private foundations. This success stems from a research-driven environment and strong collaborations between surgeon-scientists and research faculty.
The division leads several clinical trials and sponsored research projects poised to make lasting scientific contributions. The department’s clinical trials unit, along with partnerships in immunotherapy, medical oncology, radiology and other specialties, drives these advancements.
Among its many accolades, the division secured a four-year, $4 million grant from the National Cancer Institute to advance research on adenosine and its immune-suppressing role in the tumor environment of pancreatic ductal adenocarcinoma, a disease with a poor prognosis. The project aims to develop targeted therapies that inhibit adenosine, improving outcomes for patients with this complex disease. The grant also supports a follow-up Phase 1/2 clinical trial that expands on a previously successful combination of immunotherapy, chemotherapy and surgery. This step of the research adds a small molecule inhibitor intended to block adenosine production and help sustain antitumor immunity post-treatment. Division Chief Timothy R. Donahue, MD, is leading
DIVISION OF SURGICAL ONCOLOGY
Elevating Cancer Care to New Levels
Unlocking new possibilities through research expansion and strategic partnerships

the study in collaboration with Zev Wainberg, MD, co-director of the UCLA Health GI Oncology Program, and Caius Radu, MD, professor of molecular and medical pharmacology.
Building on this work, surgical oncologists within the division are leading additional cutting-edge clinical trials. Joseph Crompton, MD, PhD, is investigating immune-based therapy to treat melanoma. Carlie Thompson, MD, leads a breast cancer study evaluating hormone maintenance therapy for high-risk precursor lesions compared to traditional surgical approaches. Mark Girgis, MD, is exploring diagnostic PET imaging using a fibroblastactivated protein with potential applications for pancreatic, gastric and esophageal cancers. Jason Link, PhD, is co-leading a Department of Defense–funded research project evaluating cancer treatments for patients with borderline-resectable pancreatic cancer. Early findings from this study, which has enrolled 50 patients, show promising results.
“Each of these studies represents true transdisciplinary work with impactful, patientoriented outcomes,” Dr. Donahue says. “We are surgeons, but when we work collaboratively to find the optimal combination of treatments for patients, we better define the targeted role that surgery can play — and we are in the ideal space to make a difference.”
UCLA oncology surgeons, led by Mark Girgis, MD, conduct a minimally invasive surgery in the operating room.
Mark Girgis, MD, was appointed chief of the section of GI surgical oncology in 2024.
DIVISION OF SURGICAL ONCOLOGY
Engineering Innovations in Immunotherapy with Dr. Puig-Saus
The division’s newest translational researcher is pioneering the use of CAR T-cell therapy to tackle challenging solid tumors

Cristina Puig-Saus, PhD, works with a researcher in her laboratory at UCLA.
When Cristina Puig-Saus, PhD, a pioneering cancer immunologist, joined the Division of Surgical Oncology as an assistant professor in July 2024, she brought a remarkable record of innovation and discovery. Through her lab — the Puig-Saus Lab — she applies leading-edge science and bioengineering approaches to expand and refine treatment options. Her work focuses on harnessing and enhancing natural T-cell responses to cancer, with the goal of transforming patient outcomes.
While CAR T-cell therapy effectively treats blood cancers, it has limited success in solid tumors. The Puig-Saus Lab is working to change that. By uncovering the mechanisms that make T-cell therapies effective, the lab aims to develop new CAR T-cell therapies for treatment-resistant melanoma.
In a recent study published by Nature Communications, Dr. Puig-Saus and her
“If proven safe and effective in human trials, this treatment presents an exciting prospect for future advancements in the fight against cancer.”

team developed an engineered CAR T-cell therapy that successfully eliminated cancer cells in preclinical models. The treatment demonstrated strong efficacy without causing severe side effects. These promising results represent a major advancement in treating melanoma and lay the groundwork for future clinical trials. She has secured $5.9 million in funding from the California Institute of Regenerative Medicine to continue advancing CAR T-cell therapy for melanoma. “If proven safe and effective in human trials, this treatment presents an exciting prospect for future advancements in the fight against cancer,” Dr. PuigSaus says.
Christina Puig-Saus, PhD, assistant professor, Department of Microbiology, Immunology, and Molecular Genetics
Dr. Puig-Saus has held postdoctoral and other research positions at UCLA, during which time her research gained significant traction. Her efforts have resulted in high-profile publications in leading scientific journals, including Nature. Her transition to surgical oncology elevates the division’s position as a research leader in the field.
DIVISION OF SURGICAL ONCOLOGY
Advancing Patient Care at the UCLA Agi Hirshberg Center for Pancreatic Diseases
A renovated clinical space and new tools are improving the care experience for pancreatic disease patients
The UCLA Agi Hirshberg Center for Pancreatic Diseases, one of the nation’s leading programs for pancreatic cancer treatment and research, recently unveiled its state-of-the-art clinical space. Located within the UCLA Pfleger Liver Institute at the Vatche and Tamar Manoukian Medical Building in UCLA Health’s Medical Plaza, the light-filled suite offers serene views of the Pacific Ocean. The modern clinical space integrates several new upgrades, enhancing the experience for both patients and caregivers.
Canopy Cancer Collective:
This synergistic learning network is breaking new ground in pancreatic cancer treatment by connecting UCLA Health with a dozen peer institutions. Driven by data and shared urgency to deliver the best possible care, the program expands access to essential services, such as patient education, genetic testing, nutrition support, clinical trials, quality of life resources and palliative care.
ePRO Platform:
In 2024, the Hirshberg Center launched an electronic patient-reported outcomes (ePRO) platform that regularly surveys patients on their progress and queries them about needed services, such as clinical trials, psychosocial services, palliative care expertise and nutrition needs. According to Division Chief Timothy R. Donahue, MD, the platform helps the team identify needs faster, allowing the division to provide optimal care for all. “Where you live should not determine the quality of care you receive,” he shares.
Patient Navigator:
Funded by the Hirshberg Foundation, this newly established role helps patients navigate the complexities of the UCLA Health system, ensuring a more seamless experience. The patient navigator also provides patients with educational resources while tracking outcomes to proactively address evolving needs.

Leadership and donors attend a
ribbon-cutting ceremony for the UCLA Agi Hirshberg Center for Pancreatic Diseases.
Division of Thoracic Surgery


Vignesh
Sha’Shonda
Paul
Robert A. Cameron, MD
Jay M. Lee, MD
Raman, MD, MHS
L. Revels, MD, MS
A. Toste, MD
Jane Yanagawa, MD
Bryan M. Burt, MD Division Chief
FACULTY
DIVISION OF THORACIC SURGERY
Bridging Science and Surgery to Pioneer Breakthroughs in Cancer
New lab advances biomarker research, intraoperative innovation and personalized treatment

To bridge the gap between scientific investigation and clinical applications, the Division of Thoracic Surgery launched the Laboratory of Thoracic Innovation & Translation (TITAN). The laboratory will translate innovative surgical techniques and treatments from bench to
bedside, accelerating progress in biomarker discovery, platform development and understanding mechanism of disease. Bryan M. Burt, MD, division chief and principal investigator, partnered with Robert A. Cameron, MD, to establish the lab. The growing laboratory team includes a scientist,
M. Burt,
Duo Xu, MD, PhD, and surgery residents, Alberto Antonicelli, MD, and Simón Esteva, MD. Dr. Esteva earned the prestigious Department of Surgery Levey Award to fund his new position.
One of the lab’s first major initiatives is an NIH-funded effort to develop a novel
“By tailoring therapy to each patient’s tumor profile, our division strives to improve survival in patients with thoracic malignancies and refine new standards for thoracic cancer care.”
platform of mass-spectrometry proteomics for rapid cancer diagnosis and margin assessment in lung cancer, esophageal cancer and mesothelioma. “Both the rapid detection of malignancies and the assessment of resection margins are critical to intraoperative decision-making, and the accelerated assessment of both can decrease the time patients spend in the operating room,” Dr. Burt explains. “This improves safety and has the potential to transform the way we conduct surgical resection of malignancy.”
The new laboratory extends the division’s long-standing commitment to innovation, complementing its portfolio of industry-leading clinical trials and treatment protocols. Under the leadership of Jay Lee, MD, the thoracic oncology team continues to lead trials of novel therapies for lung cancer and thoracic malignancies, including innovative perioperative therapies. “By tailoring therapy to each patient’s tumor profile,” Dr. Burt explains, “our division strives to improve survival in patients with thoracic malignancies and refine new standards for thoracic cancer care.”
Bryan
MD, division chief (right), works with a researcher in the Translational Thoracic Surgery Laboratory at UCLA.
DIVISION OF THORACIC SURGERY
Expanding Access to Early Lung Cancer Detection
Outreach events promote screenings and education, especially in high-risk populations
Sha’Shonda L. Revels, MD, MS, is leading a study titled “Breaking Barriers in Lung Cancer Screening,” funded by the American Association for Thoracic Surgery. This project is a collaboration with county and community hospitals in underserved areas in Los Angeles that assesses the needs of patients and providers to establish an effective and accessible lung cancer screening among the county’s most vulnerable patients. “Our study has a human-centered design where we put people first and ask them directly about their challenges,” Dr. Revels says. The sites include Harbor UCLA Medical Center, Olive View-UCLA Medical Center and Martin Luther King Jr. Community Hospital and celebrate life cancer ministries.
With support from UCLA’s Office of Health Equity and Inclusive Excellence, Dr. Revels additionally supports the Lung Cancer Screening Program to promote early detection, particularly in Black and Latino communities, where rates of latestage diagnosis are disproportionately high. Partnering with the UCLA Cancer Services Committee and Population Health, Dr. Revels is establishing a tool to evaluate social determinants of health to preemptively address issues before surgery and assist patients in their cancer care journey in the thoracic clinic as a pilot and then establish the program across all cancer clinics.

DIVISION OF THORACIC SURGERY
Honoring Milestones in Clinical Excellence
Clinical care is an unwavering touchstone for the Division of Thoracic Surgery, with new and well-established programs alike celebrating achievements this year
UCLA Health’s Pulmonology and Lung Surgery Program earned the No. 3 ranking nationwide on the U.S. News & World Report list in 2024, signifying high performance in thoracic patient care.
The UCLA Robert G. Kardashian Center for Esophageal Health celebrated its fifth anniversary in 2024. At a special event marking the milestone, Jane Yanagawa, MD, surgical director, highlighted the center’s whole-health approach, with the late Robert Kardashian’s daughters in attendance. Dr. Yanagawa praised the center’s integrative model of care “that goes way beyond our conventional ideas of what constitutes medical treatment.” She emphasized the efforts of dietitians, psychologists, speech pathologists and specialized nurses who collaborate with physicians and surgeons across multiple specialties and subspecialties.
The Mesothelioma Program continues to be an international leader for treatment of this rare and aggressive cancer type. Led by Robert A. Cameron, MD, UCLA Health offers novel treatment pathways that include intensitymodulated radiation therapy and cryotherapy in the fight against mesothelioma. To better serve mesothelioma patients, the program now has a dedicated nurse practitioner assisting with patient education and navigation.
The surgical team is expanding. The Division of Thoracic Surgery successfully recruited Vignesh Raman, MD, MHS, a surgeon-scientist who will soon be joining the faculty to serve our patients at Harbor UCLA and our UCLA Health hospitals with plans to begin a translational research program in oncogenomics.

The Division of Thoracic Surgery team at UCLA
Division of Vascular and Endovascular Surgery

Vincent L. Rowe, MD Division Chief
Mark J. Ajalat, MD
Warren Chow MD, MS
Steven M. Farley, MD
FACULTY
Hugh A. Gelabert, MD
Juan C. Jimenez, MD, MBA
Bernardo C. Mendes, MD
Jessica B. O’Connell, MD
David A. Rigberg, MD
John C. Rollo, MD
Jesus Ulloa, MD
Karen Woo, MD, PhD
Jane K. Yang, MD

Peter Lawrence, MD, Distinguished Professor of Surgery Emeritus
DIVISION OF VASCULAR AND ENDOVASCULAR SURGERY
Expanding Access and Enhancing Expertise
The continued evolution of the UCLA Aortic Center, along with expanded advanced vascular services, strengthens the division’s reach and impact
In 2024, the UCLA Division of Vascular and Endovascular Surgery expanded its services, reinforcing its leadership in aortic care and bringing specialized vascular expertise to even more patients.
Growing the Aortic Center
The UCLA Aortic Center consistently raises the standard for comprehensive aortic disease treatment, uniting a multidisciplinary team of surgeons, cardiologists, radiologists, anesthesiologists and other specialists. This collaborative approach ensures the highest level of diagnosis, treatment and research innovation.
This year, two major advancements solidified the center’s authority. First, the addition of a state-of-the-art hybrid operating room enables seamless coordination between open surgical and endovascular procedures, allowing precise, effective treatment of complex cases. Second, the arrival of Bernardo Mendes, MD, a world-renowned vascular surgeon specializing in complex aortic conditions, further elevates UCLA Health’s clinical expertise and reinforces its leadership in aortic care.
Expanding Vascular Surgery to the West Valley
Expanding access to vascular surgery is a top priority for Vincent L. Rowe, MD, division chief and newly appointed president of the Society for Clinical Vascular Surgery (2025–26). As a nationally recognized leader in the field,

Dr. Rowe brings both clinical expertise and visionary leadership to UCLA Health’s regional vascular program.
At the newly acquired UCLA West Valley Medical Center, he has already begun seeing patients and leading the launch of a vascular
surgery department to meet growing demand. Later this year, a vascular surgeon will join the team to further enhance access and continuity of care.
“Our expansion to the West Valley allows us to provide dedicated, full-time
vascular care rather than responding on an as-needed basis,” Dr. Rowe says. “It’s a strategic investment in providing the best possible clinical care for the community and strengthening our presence in the region.”
Community Outreach: PAD Screenings for Underserved Patients
Access to vascular care is not always equitable, and the Division of Vascular and Endovascular Surgery is committed to bridging that gap. Through a partnership with Martin Luther King Jr. Community Hospital, Charles R. Drew University of Medicine and Science and the Vascular Cures Foundation, the division is laying the groundwork for implementing an outreach initiative focused on peripheral arterial disease (PAD), a condition that restricts blood flow to the legs. With plans to hold quarterly outreach clinics, the division is working to ensure that more people receive the early intervention they need to prevent serious complications.
Bringing Advanced Vascular Care to More Patients
These initiatives reflect an unwavering commitment to expanding access, enhancing expertise and delivering worldclass vascular care to the community. From advanced aortic procedures to community outreach, the division is shaping the future of vascular health — one patient, one innovation and one community at a time.
Division Chief Vincent L. Rowe, MD
DIVISION OF VASCULAR AND ENDOVASCULAR SURGERY
Raising the Bar for Educational Excellence
A focus on educational initiatives enhances learning opportunities for all
The UCLA Division of Vascular and Endovascular Surgery is shaping the future of vascular medicine through innovative education programs. In 2024, the team implemented two significant initiatives to enhance learning opportunities for practicing medical professionals and aspiring vascular surgeons.
Inaugural Wound Care Symposium
To address a gap in local educational offerings, UCLA hosted “What’s New in Wound Care and Limb Salvage?” a one-day, in-person and virtual symposium focused on the latest advancements in wound care. Held in September 2024, the event was one of the first of its kind in the Los Angeles area and attracted over 100 attendees from various health systems, surpassing expectations.
Directed by Steven Farley, MD, and Aksone Nouvong, DPM, the multidisciplinary program featured expert insights from UCLA specialists in vascular medicine, podiatry, plastic surgery and internal medicine. Attendees explored topics such as wound etiology, treatment options, diagnostic techniques and the benefits of cross-specialty collaboration.
“We received overwhelmingly positive feedback,” Dr. Rowe explains. “This symposium filled a critical educational need in our community, and I expect that based on this year’s successful inaugural program, we’ll host another symposium in 2025.”
Vascular Surgery Residency Launches a Research Year
In 2024, the Integrated Vascular Surgery Residency Program launched a dedicated research year to give residents deeper academic and clinical experience.
“Our residents are already exceptional, but this addition strengthens their academic experience,” Dr. Rowe says. “We’ve received positive feedback from both faculty and program applicants, reinforcing the value of this important initiative.”
After their third year of residency, participants will spend a dedicated year conducting in-depth research in their area of interest. Residents may explore the plentiful research opportunities available at UCLA, while also tapping into our national network of leading vascular surgery collaborators. This tailored approach broadens their expertise and prepares them to drive meaningful advancements in the field.
A Commitment to Excellence
Through these initiatives, the UCLA Division of Vascular and Endovascular Surgery continues to push the boundaries of education and training. By fostering innovation and collaboration, the team is shaping the next generation of vascular specialists and reinforcing UCLA’s role as a leader in medical education.

SURGICAL EDUCATION
Advancing Surgical Education: Growth, Outreach and Excellence
Initiatives reach students and trainees at each pivotal stage of the educational journey
The UCLA Department of Surgery is committed to providing next-level excellence in surgical education — a commitment reflected in awards, new training programs and expanded mentorship opportunities.
“We have a lot to celebrate this year as we continue to invest in the next generation,” says Areti Tillou, MD, vice chair for education and trauma surgeon. “Our focus is on providing high-quality educational and training opportunities to support the success of our surgeons and academic leaders at every phase of their career.”
Faculty Excellence and New Roles
In recent years, the David Geffen School of Medicine (DGSOM) at UCLA recognized surgical faculty with numerous teaching accolades.
In 2024, Melinda Maggard-Gibbons, MD, MSHS, professor in residence, Division of General Surgery, won the DGSOM Wilbur S. Schwartz MD Prize for Kindness, Compassion and Humanity. Other departmental awardees of this honor include Justin P. Wagner, MD, pediatric surgeon (2023); Formosa C. Chen, MD, colon and rectal surgeon (2022); Timothy R. Donahue, MD, division chief of surgical oncology (2022); Sha’Shonda L. Revels, MD, colon and rectal surgeon (2021); and Dr. Tillou (2020). Additionally, Catherine J. Juillard, MD, MPH, trauma surgeon, was honored with the prestigious Academic Global

Surgeon Award — one of only five recipients of the 2024 ACS/Pfizer Surgical Volunteerism and Humanitarian Awards.
Darryl Hiyama, MD, professor of clinical surgery, has been selected as a recipient of the 2025 Serge & Yvette Dadone Clinical Teaching Award, recognizing his exceptional dedication to medical education. His lasting impact on trainees and colleagues
“Our faculty go above and beyond to shape the future of surgery. Their dedication leaves a lasting impact on our students and trainees, and it is truly gratifying to see them recognized for their hard work.”

will be celebrated at the Awards for Education Reception and the DGSOM Commencement Ceremony.
“Our faculty go above and beyond to shape the future of surgery,” Dr. Tillou says. “Their dedication leaves a lasting impact on our students and trainees, and it is truly gratifying to see them recognized for their hard work.” (continued on next page)
Areti Tillou, MD, vice chair for education
Bijan Najafi, PhD, director of research for the Center for Advanced Surgical and Interventional Technology (CASIT) and members of the CASIT team.
SURGICAL EDUCATION
Advancing Surgical Education: Growth, Outreach and Excellence
(Continued)


In faculty transitions, Bijan Najafi, PhD, joined the Center for Advanced Surgical and Interventional Technology (CASIT) as director of research. Jane Yanagawa, MD, became program director for the General Surgery Residency, succeeding Dr. Donahue after many years of successful leadership.
Expanding Training Programs and Courses
The department is committed to developing tomorrow’s surgical leaders. To support this goal, it consistently offers training programs and skills courses for residents, fellows and faculty at all stages of medical education. In the last academic year, course offerings and CASIT activities have increased by over 20%. Highlights from this fiscal year include:
• With the launch of the Advanced Trauma Life Support (ATLS) Instructor Course, UCLA joined a handful of institutions across the country approved by the American College of Surgeons to train physicians to become ATLS instructors. This course attracts out-of-state and international participants.
• Nimmi Kapoor, MD, breast surgeon, led the Breast Ultrasound, Intra-operative Wire Localization, and Oncoplastic Skills Course for Surgeons. The course generated significant interest, with many requesting additional training sites across California.
• The American College of Surgeons selected UCLA Health as the host site for its national surgical skills course, where 20 top-tier participants refined their techniques under expert guidance. Dr. Kapoor served as course director.
• The department held the Johnson & Johnson Future Leaders Program, providing surgery
residents direct training, leadership development sessions and opportunities to engage with influential changemakers in surgery.
• CASIT hosted the UC Simulation Symposium, drawing over 100 medical educators, faculty and residents from across the state. (Read more about CASIT on page 52 of this report.)
• The Division of Vascular and Endovascular Surgery hosted a course on “What’s New in Wound Care and Limb Salvage?” The event was well received by more than 100-plus participants and will become an annual offering. (Read more on page 44.)
Mentorship at the Community Level
The High School Pre-Med Summer Scholar Program is an immersive five-day program offering high school students a unique opportunity to engage directly with the world of medicine through hands-on activities, expert-led sessions, and behind-the-scenes exposure to clinical environments. Participants explore various medical specialties, engage in interactive workshops, and hear from accomplished physicians, surgeons and health care professionals who share insights about their career paths and the realities of working in medicine. The program not only equips students with practical knowledge but also inspires them to envision themselves in future health care roles. In response to growing interest and demand, the program expanded significantly in 2025, welcoming more than 300 participants — its largest cohort since inception. This milestone reflects the program’s increasing popularity and impact, as well as the Department of Surgery’s dedication to fostering early interest in medical careers among motivated students (continued on next page)
Nimmi Kapoor, MD, breast surgeon (center), led the Breast Ultrasound, Intra-operative Wire Localization, and Oncoplastic Skills Course for the American College of Surgeons.
SURGICAL EDUCATION
Advancing Surgical Education: Growth, Outreach and Excellence
(Continued)
from diverse backgrounds. By investing in this early pipeline initiative, the department continues to demonstrate its commitment to building a future health care workforce that is skilled, passionate and well-prepared to meet the evolving needs of patients and communities.
New Residency and Fellowship Opportunities
Residency and fellowship opportunities expanded this year, thanks to the concentrated efforts of faculty and administration.
The General Surgery Residency expanded its complement to eight residents, marking an exciting step forward for the program.
A new Facial Gender-Affirming Surgery Fellowship launched in June 2025. The Surgical Critical Care Fellowship proudly graduated its first fellow in 2024 and the Acute Care Surgery Fellowship celebrated its first graduate in 2025. The Congenital Cardiac Surgery Fellowship development process is in its final stages as the ACGME site visit has been successfully completed. The projected fellowship start date is August 2026, pending ACGME approval.
“With internationally recognized faculty and a high patient volume, we are in a strong position to bring back this program,” Dr. Tillou says.
All training programs remain fully accredited, reflecting the department’s continued commitment to excellence.

Medical Student Achievements
Aakrsh Misra, a UCLA undergraduate, received an award for his presentation on surgical workplace culture at the Association for Surgical Education Conference — one of only three undergraduates globally invited to present.
Resident Achievements
Brittany Robinson, MD, was selected as a 2025–2026 UCGHI GloCal Health Fellow. Sponsored through UCLA, the fellowship supports 12 months of research training in Cameroon, where Dr. Robinson will collaborate with mentors to advance global health research.
Kyle D. Klingbeil, MD, MS, received a Discover Award from Tempus, a genetic sequencing company, for his research proposal on the molecular profiling of gastric cancer by race and ethnicity. The project builds on his existing work in Los Angeles,
where data shows that Hispanic ethnicity is associated with worse survival outcomes in gastric cancer.
Serena Lofftus, MD, was awarded Best Trainee at the 2025 Pacific Coast Surgical Association conference in Kailua-Kona, Hawaii. The senior author on the paper was Dr. Jennifer Baker.
Jordan Rook, MD, won the top research award at the American Pediatric Surgical Association 2025 annual meeting. He is expected to complete his PhD in Health Policy and Management in August 2025. His dissertation is titled “The Cost of Health as the Bottom Line of Health Care Policies: Deductible-Based Cost Sharing and the 2021 Expanded Child Tax Credit.”
Whitney Orji, MD, MSHP , was accepted into the Society of Black Academic Surgeons’ Diverse Surgeons Initiative 2.0. Dr. Orji was selected through a highly competitive process, which included over 50 qualified applicants.
Dominic Amara, MD, MS , received a UCLA STAR Award in recognition of his outstanding research, academic potential and leadership. The award includes salary, tuition, fees and protected time for advanced degree training, along with mentorship and participation in STAR Program seminars.
Transitions, Match Highlights and Awards
General Surgery
Transitions
• Kevin James Blair, MD, general surgery resident, started the surgical critical care and trauma and acute care surgery fellowship at the University of Colorado-Denver.
• Joseph Hadaya, MD, general surgery resident, started a fellowship with UCLA’s Division of Thoracic Surgery.
• Ivy Huang, MD, general surgery resident, started a colorectal surgery fellowship at Hospital of the University of Pennsylvania.
• Garrett Salzman, MD, general surgery resident, started a surgical critical care fellowship at UCLA.
• Benjamin Tran, MD, general surgery resident, started a liver transplant fellowship at Mount Sinai.
• Dennis Zheng, MD, general surgery resident, started a surgical critical care fellowship at the University of Washington.
• Zachary Weitzner, MD, general surgery resident, started a minimally invasive and bariatric surgery fellowship at Duke University Hospital.
Matches
• Connor Bridges, MD, completed medical school at Geisel School of Medicine at Dartmouth and started a general surgery residency with UCLA in 2025.
• Sofia Fabrega, MD, completed medical school at University of Arizona College of Medicine and started a general surgery residency with UCLA in 2025.
• Max Frenkel, MD, completed medical school at University of Wisconsin School of Medicine and Public Health and started a general surgery residency with UCLA in 2025.
• Kevin Gianaris, MD, completed medical school at Indiana University School of Medicine and started a general surgery residency with UCLA in 2025.
• Priyanka Jadhav, MD, completed medical school at UC San Diego School of Medicine and started a general surgery residency with UCLA in 2025.
• Jessie Jiang, MD, completed medical school at University of Colorado School of Medicine and started a general surgery residency with UCLA in 2025.
• Liza Rosenbloom, MD, completed medical school at the University of Miami Leonard M. Miller School of Medicine and started a general surgery residency with UCLA.
• Cameron Speyer, MD, completed medical school at University of Michigan Medical School and started a general surgery residency with UCLA in 2025.
Surgery Education Awards 2024–25
• The following general surgery residents received the Medical Student Teaching Award: Dominic Amara, MD, MS; Kera Kwan, MD; Serena Lofftus, MD; Jose Luis Lopez, MD; Tyler McCaw, MD, PhD; Andrew Melehy, MD; Young-Ji Seo, MD; Nicholas Siena, MD; Michael Srienc, MD, MS; Serena Zheng, MD; Tess Huy, MD.
• Nicholas Siena, MD, general surgery resident, received the Jonathan R. Hiatt Excellence in Medical Student Education Award, named after Jonathan R. Hiatt, MD, emeritus professor of surgery.
• Maya Alexis, MD, general surgery resident, received the Outstanding R1 Award, and Kyla Wright, MD, general surgery resident, received the Outstanding R2 Award
• Joseph Hadaya, MD, general surgery resident, received the Gerald S. Levey Surgical Education Award and the Howard A. Reber Golden Scalpel Award for most outstanding performance as chief resident.
• Ivy Huang, MD, general surgery resident, received the Ronald K. Tompkins Golden Apple Award for outstanding teaching of medical students.
• Kevin James Blair, MD, general surgery resident, received the Henry Cryer Award.
• The following general surgery residents received ABSITE Awards: Phifer Nicholson, Jr, MD, MTS, PGY1; Kyla Wright, MD, PGY2; Serena Lufftus, MD, Research; Joon Park, MD, PGY3; Amanda Labora, MD, PGY4; Ivy Huang, MD, PGY5.
Vascular Surgery
Transitions
• Annie Mooser, MD, vascular surgery fellow, was hired as assistant professor by the Uniformed Services University of the Health Sciences.
• Amanda Chin, MD, vascular surgery resident, started as an attending at Kaiser Permanente.
Matches
• Armin Tabiei, MD, completed medical school at Karolinska Institute and will be starting a vascular surgery residency with UCLA in 2025.
• Jee Hoon Song, MD, completed a general surgery residency at Loma Linda University School of Medicine and will be starting a vascular surgery fellowship with UCLA in 2025.
Transitions, Match Highlights and Awards
(Continued)

Podiatry
Transitions
• Branda Bui, DPM, podiatry resident, was hired as an attending by the Antelope Valley VA Clinic.
• Christine Chester, DPM, podiatry resident, is an attending at Los Angeles General Medical Center.
• Karishma Patel, DPM, podiatry resident, is a UCLA Health System UPG provider.
• Parth Patel, DPM, podiatry resident, is an attending with UCLA Health System.
Matches
• Edward Chen, DPM, completed medical school at Western University of Health Sciences COPM and will be starting a podiatry residency with UCLA in 2025.
• Kathryn Drees, DPM, completed medical school at Kent State University and will be starting a podiatry residency with UCLA in 2025.
• Riley Thomas, DPM, completed medical school at Western University of Health Sciences COPM and will be starting a podiatry residency with UCLA in 2025.
• Megan Vo, DPM, completed medical school at Western University of Health Sciences COPM and will be starting a podiatry residency with UCLA in 2025.
Plastic Surgery
Transitions
• Leila Musavi, MD, plastic surgery resident, started a microsurgery fellowship at Memorial Sloan Kettering Cancer Center.
• Nirbhay Jain, MD, plastic surgery resident, started a hand fellowship at University of Pittsburgh.
• Jake Alford, MD, plastic surgery resident, started a plastic surgery fellowship at Cook Children’s Hospital.
Matches
• Natalie Baxter, MD, completed medical school at the University of Michigan Medical School and started a plastic surgery residency with UCLA in 2025.
• Kassra Garoosi, MD, completed medical school at the University of Colorado School of Medicine and started a plastic surgery residency with UCLA in 2025.
• Dylan Treger, MD, MBA, completed medical school at the University of Miami Leonard M. Miller School of Medicine and started a plastic surgery residency with UCLA in 2025.
Surgery Education Awards 2024–25
• Leila Musav, MD, plastic surgery resident, was awarded the Resident Research Award 2025
• Brendan Cohin, MD, plastic surgery resident, was awarded the Best Resident Teacher Award 2025.
Microsurgery
Matches
• Salma Abdou, MD, completed a plastic surgery residency at Georgetown University and will be starting a microsurgery fellowship with UCLA in 2025.
• Kristen Whalen, MD, completed a plastic surgery residency at the University of South Florida and will be starting a microsurgery fellowship with UCLA in 2025.
Gender-Affirming Surgery
Matches
• Lee Weber, MD, completed a plastic surgery residency at the University of Miami and will be starting a genderaffirming surgery fellowship with UCLA in 2025.
Transitions, Match Highlights and Awards
Thoracic Surgery
Transitions
• Ryan Vela, MD, thoracic surgery fellow, is now a cardiothoracic surgeon at Community Memorial Hospital and Ventura County Hospital Ventura.
• Ryan Bedi, MD, thoracic surgery fellow, is now a cardiothoracic surgeon at Hoag Hospital Newport Beach.
Matches
• Joseph Hadaya, MD, completed a general surgery residency at UCLA and started a thoracic surgery fellowship with UCLA in 2025.
• Aaron Tipton, MD, completed a general surgery residency at Case Western Reserve University and started a thoracic surgery fellowship with UCLA in 2025.
Surgery Education Awards 2024–25
• Ryan Bedi, MD, thoracic surgery fellow, received the Robert Rosenberg Humanitarian Award.
• Alexey Abramov, MD, thoracic surgery fellow, and Matthew Gandjian, MD, thoracic surgery fellow, received the Blalock Resident Travel Award.
• Carolyn Smullin, MD, general surgery resident, received the Thoracic Senior Resident Award.
• Shahrzad Moghadam, MD, general surgery resident, received the Thoracic Junior Resident Award.
Surgical Critical Care
Transitions
• Tonny Orach, MD, surgical critical care fellow, is now a trauma and acute care surgeon at Phoebe Putney Memorial Hospital.
Matches
• Briana Britton, MD, completed a general surgery residency at St. Joseph’s Hospital and started a surgical critical care fellowship with UCLA in 2025.
Acute Surgery Care/Trauma
Transitions
• Michaela Bamdad, MD, acute care surgery/trauma fellow, was hired as assistant professor in the Department of Surgery, Division of Trauma and Surgical Critical Care at Yale New Haven Hospital.
Breast Surgical Oncology
Transitions
• Siu-Yuan Huang, MD, breast surgical oncology fellow, is now a surgical oncology breast surgeon at Santa Clara Valley Medical Center.
Matches
• Jessica Kieu, MD, completed a general surgery residency at the University of Hawaii and started a breast surgical oncology fellowship with UCLA in 2025.
Endocrine Surgery
Transitions
• Joshua Chao, MD, endocrine surgery fellow, was hired as an assistant professor of surgery at Albany Medical Center.
Matches
• Hope Feldman, MD, completed a general surgery residency at Geisinger Medical Center and started an endocrine surgery fellowship with UCLA in 2025.
Liver Transplant
Transitions
• Caitlin J. Thornley, MD, liver transplant fellow, is now a liver transplant surgeon at Memorial HermannTexas Medical Center.
• Valeria Ripa, MD, liver transplant fellow, is now a kidney transplant surgeon at Cooperman Barnabas Medical Center.
Matches
• Bryan Myers, MD, completed a general surgery residency at Icahn School of Medicine at Mount Sinai and started a liver transplant fellowship with UCLA in 2025.
• Catherine Donat, MD, completed a general surgery residency at Florida Atlantic University Charles E. Schmidt College of Medicine and started a liver transplant fellowship with UCLA in 2025.
Building Surgical Mastery Through Hands-On Learning
Cadaver training and sophisticated equipment help faculty, trainees and students develop world-class surgical expertise
Anatomy is the foundation of surgical practice. The better a surgeon understands anatomy, the better they perform in the operating room. The Surgical Science Laboratory (SSL) at UCLA Department of Surgery provides surgeons, trainees and students with a low-stress environment to refine their skills.
Equipped with a wide range of cadavers and state-of-the-art technology, SSL offers opportunities to achieve surgical mastery and develop new techniques.
“Our surgeons in the lab operate under the most sophisticated conditions,” says Warwick Peacock, MD, director of SSL and pediatric neurosurgeon.
Lifelong Learning
Each year, SSL welcomes students at various stages of their education. Around 250 high school students attend introductory sessions, while UCLA undergraduates gain direct experience with dissection and surgical basics. Medical students in their third and fourth years use the lab to learn basic surgical skills such as suturing.
The lab primarily supports interns and residents. With guidance from Dr. Peacock and other faculty, surgical trainees perform dissections on whole cadavers as well as targeted regions of the body based on their specialties. Experienced surgeons also use the lab to refine their skills and invent new techniques.
Advancing Surgical Innovation
In 2024, SSL was instrumental in UCLA Health’s groundbreaking research by providing a safe environment to assess and refine surgical techniques.
Dr. Peacock and Aya Barzelay-Wollman, MD, PhD, ophthalmologist, lead a multicenter research project focused on eye harvesting and transplantation. The multidisciplinary team is exploring the optimal surgical approach for donor eye retrieval and transplantation.
Additionally, the lab supports UCLA Health’s new bladder transplant program.
Dr. Peacock collaborates with Nima Nassiri, MD, urologist and transplant surgeon, to develop nerve-preserving bladder transplant procedures that could improve patient outcomes and quality of life.
A New Type of Anatomy Textbook
Dr. Peacock is developing a fourth edition of “Dissection Anatomy for General Surgeons,” taking an entirely new approach, inspired by his work at the laboratory.
“You can’t learn anatomy without dissection,” he emphasizes.
The book offers a step-by-step guide to anatomical structures, dissections and surgical techniques. Produced entirely at UCLA, the book contains illustrations based on Dr. Peacock’s and his colleagues’ dissections in the lab.
From training to innovation, SSL is essential to UCLA Health’s mission of surgical excellence.


Surgical Science Laboratory students and trainees refine their surgical skills in a lowstress environment.
CENTER FOR ADVANCED SURGICAL AND INTERVENTIONAL TECHNOLOGY
Designing AI-Powered Solutions Across the Continuum of Care
Advances in robotic surgery and remote health technologies are reshaping how surgeons operate — and how patients recover

At UCLA’s Center for Advanced Surgical and Interventional Technology (CASIT), the future of surgery is taking shape in real time. This interdisciplinary hub unites engineers, data scientists and clinicians from across UCLA Health and the David Geffen School of Medicine. The center aims to advance precise and accessible health care. This year marked a pivotal moment for CASIT with the appointment of Peyman Benharash, MD, cardiac surgeon, as the executive director and Bijan Najafi, PhD, bioengineer, as the research director. Their leadership comes at a key moment, as the center intensifies its focus on artificial intelligence (AI) and home-based technologies.
With an expanding portfolio of innovative technology, CASIT is redefining care beyond hospital walls. Current projects include platforms that support at-home recovery after chemotherapy, remote monitoring systems for chronic conditions like diabetic foot ulcers and wearable technologies to alleviate long COVID-19 symptoms. Researchers are developing wearable devices to detect early indicators of neurodegenerative diseases such as dementia and Alzheimer’s. To prevent decline, CASIT is creating gamified mind-body exercises to support cognitive and physical rehabilitation. The team also develops AI-driven solutions designed to mitigate social isolation and loneliness.
In parallel, CASIT researchers are advancing telemedicine by enhancing image and video analysis, enabling clinicians to remotely assess physical symptoms and cognitive functioning. This technology strengthens diagnosis and treatment planning from a distance.
Among the center’s flagship breakthroughs is a haptic feedback system two decades in development. Its AI-powered transducers detect subtle differences in tissue composition and internal pressure — a “major advancement in the future of robotic surgery,” notes Dr. Benharash.
Designed for integration into surgical robots or direct implantation, these sensors provide real-time, high-precision feedback that supports complex procedures involving delicate nerves and blood vessels.
Driving Collaborative Discovery
As an official partner of the National Science Foundation Industry-University

Cooperative Research Centers’ Center to Stream Healthcare in Place (C2SHIP), CASIT continues to expand its reach through strategic alliances. C2SHIP unites six U.S. universities, 20 industry partners and the National Science Foundation to advance home-based health care technologies.
At the biannual meetings, academic researchers present novel ideas while industry and government partners offer insight on development pathways and regulatory considerations. This dynamic exchange positions CASIT to translate innovation into real-world impact. “We have great clinicians with a clear vision for the future at UCLA Health,” says Dr. Najafi. “They are open to thinking outside the box and trying something new.”
With every breakthrough, CASIT is shaping a future where surgery is smarter, recovery is faster and care reaches patients wherever they are.

A medical student uses a robotic surgery simulator.
FACULTY WELLNESS
Elevating Wellness and Advancement in Academic Surgery
Well-being programs and academic advancement initiatives provide vital support for faculty members
Surgeons rigorously train to manage high-pressure environments. However, the increasing demands of academic surgery — balancing complex procedures, research, teaching and career advancement — may negatively affect professional and personal well-being. For the UCLA Department of Surgery, faculty well-being is not just a buzzword; it is a strategic priority. Through targeted programs, the department is addressing stress, burnout and professional growth, ensuring faculty have the tools they need to succeed.
Veronica Fair Sullins, MD, the department’s wellness officer and pediatric surgeon, advances faculty well-being through programs designed to reduce stress and improve performance.
One key initiative is Enhanced Stress Resilience Training (ESRT), a mindfulness program tailored to the unique challenges of physicians and surgeons.
Developed at UCSF Health, ESRT teaches surgeons cognitive techniques to manage stress effectively, even when exhausted or overloaded with information. The goal? To make stepping back and gaining perspective

as instinctual as tying a surgical knot. ESRT began at UCLA Health in 2020 as an annual five-week course for residents, teaching formal techniques like meditation and informal skills like breath awareness. Now, Dr. Sullins is spearheading its expansion to faculty, which includes hiring a full-time well-being instructor for the Department of Surgery.
Additionally, through the Well-Being in Surgery (WISe) Collaborative, a formal collaboration with the UCSF Department of Surgery, UCLA is establishing a dedicated wellness hub for surgeons.
“The goal is to be a center of gravity for direct interventions, community building, research, scholarship and advocacy for surgical well-being,” she says, “and to lead this essential and rapidly evolving field.”

Melinda Maggard-Gibbons, MD, MSHS, was appointed the inaugural Special Advisor for Clinical Professionalism for the David Geffen School of Medicine.
Navigating the Path to Academic Advancement
Beyond the OR, academic surgeons must also navigate the complex process of career advancement — a challenge that often comes with little guidance. Melinda Maggard-Gibbons, MD, MSHS, vice chair for academic affairs and general surgeon, explains, “Faculty members face a significant workload when preparing for academic actions, whether it’s an advancement or a promotion, all while balancing clinical demands,” noting the extensive documentation and requirements involved.
To provide better support, the Academic Personnel Office (APO) streamlined the advancement process by clarifying submission requirements and deadlines while also offering one-on-one meetings to guide faculty through the process. As part of this effort, Dr. Maggard-Gibbons and three APO staff members met with 20 faculty members seeking advancement this year.
“We assist faculty both proactively and when issues arise,” Dr. Maggard-Gibbons says. “The vision is to continue to improve our guidance efforts each year.” To that end, a formal faculty development program is in the works, targeted to start this academic year.
Expanding Surgical Care Across Southern California
Integration into new hospitals expands UCLA Health surgeons’ reach, bringing world-class care closer to home
UCLA Health is committed to delivering world-class care to the vast and diverse Los Angeles metropolitan area. While its primary care network has expanded significantly over the past decade, surgery presents a uniquely distinct set of challenges. Surgical care requires specialized equipment, dedicated operative space, postoperative recovery beds and access to acute care units.
For patients outside Westwood and Santa Monica, the burden of traveling — often exacerbated by Los Angeles’ notorious traffic — meant people sought care elsewhere. “We were losing patients to local doctors because we weren’t accessible,” explains Avital Harari, MD, MBA, MSc, vice chair of ambulatory surgery and endocrine surgeon.
To close this gap, UCLA acquired West Valley Hospital in the San Fernando Valley, now UCLA West Valley Medical Center. Simultaneously, the Department of Surgery is integrating into Martin Luther King Jr. Community Hospital (MLKCH) in South Los Angeles.
Over the next year, UCLA Health will focus on renovating UCLA West Valley Medical Center, integrating its electronic medical record system and embedding staff, including a new chief of general surgery and surgeons from a majority of our divisions.
In parallel, the collaboration with MLKCH will require thoughtful planning to establish elective surgical care. For both hospitals, it is essential to integrate seamlessly with local surgeons who already provide care.
With a focus on access and expansion, UCLA is deepening its reach in Santa Clarita and the South Bay, exploring collaborations with local ambulatory surgery centers and hospitals. The goal is to ensure that, whenever possible, UCLA surgeons can operate in UCLA facilities — improving continuity of care and maintaining the highest standards of surgical excellence. “Our vision is to have regionalized care, with sets of surgeons who operate in specific regions,” Dr. Harari says.
As UCLA Health expands its surgical footprint, Dr. Harari remains focused on quality improvement initiatives to ensure that every patient, everywhere, receives the same exceptional care. She is also pursuing biotech collaborations to streamline patient interactions beyond the OR and support local access to care. Long term, Dr. Harari hopes to offer community training for residents and students and have surgeons teach at community sites.
“The goal is to ensure that, whenever possible, UCLA surgeons can operate in UCLA facilities — improving continuity of care and maintaining the highest standards of surgical excellence.”

“It’s a really exciting time,” she says. “Our dedication to providing care in the community is unwavering.”

Avital Harari, MD, MBA, MSc, vice chair for ambulatory surgery
Our Surgery Footprint
With 21 locations, the UCLA Department of Surgery is committed to delivering world-class care to the vast and diverse Los Angeles metropolitan area
Santa Monica
Downtown LA
Charles Drew, East LA
Harbor, Torrance
Laguna Hills
Burbank
North Hollywood
Encino
West Valley Hospital, West Hills
Westlake
Ventura
Santa Barbara
Calabasas
Porter Ranch
Olive View, Sylmar
Santa Clarita Valencia
OLIVE VIEW-UCLA MEDICAL CENTER
Streamlining Surgical Care for an At-Risk Population
A focus on efficiency and an expanding workforce creates new opportunities and improved outcomes

For the hardworking communities of the northeastern San Fernando Valley, access to timely, high-quality health care is essential. Olive View-UCLA Medical Center serves as a vital resource for this Spanishspeaking population, meeting patients where they are with compassionate care. Since joining in 2023, David Tichansky, MD, MBA, UCLA’s vice chair for surgery at Olive View, has led efforts to make health care more efficient and accessible for the patients who need it most.
“We feel privileged to help this population,” Dr. Tichansky says. From first consultation to postoperative recovery, he aims to optimize every step of the surgical journey, ensuring patients receive timely care.
Olive View performed over 6,000 surgeries in the 2024 calendar year, a number that increased 13% over the previous year.
“Everyone from the physicians to the nursing staff in the OR to the anesthesia staff has worked together to expand access to our services and to improve efficiency,” he notes. To achieve this volume increase, the team identified underutilized space, extended the surgical day by two hours, streamlined administrative tasks and enhanced operating room efficiency.
One successful case study is Olive View’s Limb Salvage Clinic, established in 2023,
which treats diabetes patients with lower limb wounds. The clinic serves as a onestop shop, uniting primary care and surgical services so patients can discuss symptom management and receive wound care.
“Rather than three appointments, patients only need one, which is a real gamechanger for this population, since when they’re here, they’re not working,” Dr. Tichansky says. In the past year, the number of amputations in this population has decreased from 15 to five, a direct result of the early intervention afforded by the clinic’s streamlined approach.
Olive View’s focus on efficiency extends to research and education. To support surgical
In the past year, the number of amputations in this population has decreased from 15 to five, a direct result of the early intervention afforded by the clinic’s streamlined approach.
residents, Dr. Tichansky hires additional advanced practice practitioners (APP), who create continuity for the patient and allow residents to focus on educationally valuable patient-care experiences. In the beginning of 2023, there was one APP for the entire department; now there are 13. “When you see residents smiling and excited to be here, that in itself is an improvement,” Dr. Tichansky says.
This fiscal year also saw the appointment of Jonathan Bergman, MD, MPH, urologic surgeon, as the Olive View vice chair of research. Dr. Bergman will support the department’s research accelerator group, streamlining the grant writing and submission process and facilitating mentorship for applicants.
Amid all this change, Olive View remains committed to its mission as a community hospital and its legacy as a premier place for surgical training and care: “The people here, the internal drive, is the same as always — just growing,” Dr. Tichansky says.

David S. Tichansky, MD, MBA, vice chair for surgery at Olive View-UCLA Medical Center
VA GREATER LOS ANGELES HEALTHCARE SYSTEM
Precision, Progress and Patient-Centered Care
From innovative programs to top surgical talent, the VA Greater Los Angeles Healthcare System is leading the way in delivering high-quality care to veterans


Research performed by several UCLA faculty members, including VA faculty Jesus Ulloa, MD, and Mark Girgis, MD, and Olive View-UCLA faculty Melinda MaggardGibbons, MD, MSHS, shows VA hospitals provide veterans with superior care and higher patient satisfaction than non-VA hospitals. The VA Greater Los Angeles Healthcare System (VAGLAHS) is committed to delivering top-tier care to our veterans, thanks to a team of leading surgeons and researchers.
Over the past year, the VAGLAHS Department of Surgery has streamlined operations and improved efficiency in the operating room, ensuring on-time starts. Additionally, the department received approval for a seven-nurse referral coordination team to help triage patients and keep them within the VA system for care.
Department Highlights
Cardiac Surgery: Marineh Bojalian, MD, and newly hired Peter Downey, MD, helped increase cardiac surgery volume from 75 to 104 last year, nearing pre-pandemic levels. The department launched a virtual aneurysm surveillance unit and introduced a telehealth
surgery program to expand local care access and treat more complex cases.
Plastic Surgery: George Rudkin, MD, led his team in publishing several peer-reviewed papers and supported Justine C. Lee, MD, PhD, as she advanced her research. Dr. Lee’s work earned three NIH grants and culminated in the prestigious Presidential Early Career Award for Scientists and Engineers (page 33). With the addition of Edward Nahabet, MD, a microsurgery expert, the department reinstated its flap surgery program and expanded its offerings of complex reconstructive procedures. Together with James Tomlinson, MD, PhD, surgical oncologist, the team also developed a multidisciplinary reconstructive surgery workflow for women veterans undergoing breast cancer treatment.
Thoracic Surgery: Robert A. Cameron, MD, was instrumental in the VALOR phase 3 trial, evaluating radiofrequency ablation as an alternative to surgery for high-risk lung cancer patients. VAGLAHS serves as the study’s quality control center.
Vascular Surgery: VAGLAHS received approval to build a hybrid operating room, expected to break ground this fall. The combination operating room and interventional radiology suite will support complex procedures that require sophisticated imaging. The departmental team, led by Jesus Ulloa, MD,
published several articles on vascular surgery clinical care in 2024.
General Surgery: James S. Tomlinson, MD, PhD, launched a robotic surgery education program that equips residents with robotic surgical skills, helping to reduce complication rates. The department is also on track to earn the Geriatric Surgery Verification from the American College of Surgeons, becoming one of the first VA centers in the country to reach this milestone.
Podiatric Surgery: The podiatry team advanced its wound care research and welcomed the expansion of its surgical team. The new UCLA Podiatric Surgery and Medicine Residency Program also launched, further strengthening training efforts. In collaboration with vascular surgery, the podiatry team is developing an outpatient model for comprehensive wound care across surgical specialties. The team recently received approval for a new wound care nurse practitioner, an instrumental addition for achieving a comprehensive outpatient model.
Through these advancements, VAGLAHS continues to lead in surgical care for veterans, combining innovation, expertise and a patient-centered approach. By expanding programs, improving efficiency and investing in top surgical talent, the team is enhancing outcomes and ensuring veterans receive the quality care they deserve.
Jessica B. O’Connell, MD, director for the surgical and perioperative careline; chief of surgery at the VA Greater Los Angeles Healthcare System
HEALING, EMPOWERING AND LIBERATING TRAUMA PROGRAM
Together We Can HEaL Trauma
The HEaL Trauma Program extends its support network, uplifting more trauma survivors across Los Angeles
Trauma is one of the leading public health challenges in the United States. While the physical injuries caused by trauma are visible, the deeper, long-term effects often go unaddressed. The Healing, Empowering and Liberating (HEaL) Trauma Program at Ronald Reagan UCLA Medical Center, launched as one of the key U.S.-based projects under the Program for the Advancement of Surgical Equity, is an innovative model that pioneers healing injuries through whole-person care.
Led by Catherine J. Juillard, MD, MPH, trauma surgeon, the clinic offers inpatient and outpatient services to address the comprehensive health of trauma patients to prevent rehospitalization. In 2024, the program expanded its staff and established vital community partnerships.
A lifetime of experiences, from family history and demographics to mental health challenges, impacts trauma recovery. To address these complexities, HEaL collaborates with psychologists, social workers and community health workers to build trust and improve quality-of-life
outcomes for trauma survivors. These specialists evaluate and address key areas of patient health, including social, psychological, financial and behavioral needs. “Partnership is one of the most determinant success factors for trauma patients,” Dr. Juillard explains. “The hope that comes with someone following up with you is unparalleled.”
“This program does not just provide services — it sparks hope. For someone without an abundance of resources, it lessens fear and creates a sense of possibility.”
For many patients, that support makes all the difference. For example, one patient struggled to see a path forward after surviving a traumatic injury. With support from their community health worker and the HEaL Trauma Program team, they found the foundation they needed to start healing. The team arranged for a safe, clean stay at a cooperative care facility and remained accessible throughout the recovery process. The patient shared that consistent follow-up and easy access to the team made the greatest difference in their care: “This program does not just provide services — it sparks hope. For someone without an abundance of resources, it lessens fear and creates a sense of possibility.”

HEaL Trauma Program patient
Jose Bojorquez and Theresa “TT” Tobias, community health workers for the HEaL Trauma Program.
Addressing Disparities Around the World

Surgical care saves lives, but millions worldwide still lack access to safe, timely treatment. The Program for the Advancement of Surgical Equity (PASE) is working to close that gap by addressing surgical disparities both locally and globally. Through long-term partnerships, research and education, PASE is expanding its impact and strengthening surgical systems in low- and middle-income countries. The program is also committed to training the next generation of
Cameroon: For the past decade, trauma surgeons Catherine J. Juillard, MD, MPH, and Ariane Christie, MD, have partnered with trauma teams in Cameroon to collect injury data to build local capacity and strengthen trauma care systems. In 2024, the PASE PROGRAM
programs, improving primary care and establishing a national policy and strategy for quality improvement.
Nigeria: Veronica Fair Sullins, MD, pediatric surgeon, continues her work with GEANCO, a nonprofit organization that leads innovative surgical programs, including the development of solar-powered maternal and infant health clinics. Dr. Sullins also collaborates with GEANCO to provide educational scholarships for young women impacted by terrorism and gender inequality in Nigeria.
leaders in surgical equity and global surgery. Here’s how PASE is driving global change — working to make surgery and trauma care a right, not a privilege:
team earned two NIH grant supplements totaling $238,312 to support this work. This year, the collaboration is driving measurable improvements in trauma care and is poised to achieve even greater impact.
Armenia: Shant Shekherdimian, MD, MPH, interim chief of pediatric surgery, continues to serve as an advisor to the Armenian Ministry of Health. He has played a key role in developing national cancer screening
Mozambique: Daniel A. DeUgarte, MD, pediatric surgeon, continues his academic partnership with Hospital Central Maputo. He also provides mentorship to general surgery resident Whitney Orji, MD, as she trains to be an academic global surgeon. Recently, Dr. Orji received the UCLA Global Health Program Collaboration Award to evaluate multidisciplinary efforts to improve pediatric surgical oncology care in Mozambique.
The PASE team, including Catherine J. Juillard, MD, MPH, and Ariane Christie, MD, (front row, second and third from left) and University of Buea collaborators at the 2025 STREAM (Sustainable Trauma Research and Mentoring) Program Annual Trauma Research Workshop in Cameroon.
Empowering Surgical Excellence at UCLA Health Through Endowed Chairs
Faculty endowments provide a critical role in advancing medicine, allowing academic surgeons the resources and security needed to excel in innovation, education and clinical care
Faculty endowments are essential to sustaining excellence in academic medicine, providing critical funding that supports top-tier educators, researchers and clinicians. These endowed positions allow faculty to pursue innovative research, mentor future surgical leaders and advance patient care while offering the freedom to explore promising new areas. They pay tribute to both the holder who has earned the distinction and the donor who has embraced the vision. The impact extends far beyond UCLA’s campus, influencing surgical practices and health care advancements worldwide.
With 22 endowed chairs currently established in the department, these positions empower surgeons to push the boundaries of medical discovery, refine lifesaving techniques and train the next generation of surgical specialists. The stability of endowed funding ensures that faculty can focus on enhancing patient outcomes, developing new surgical methodologies and expanding UCLA’s leadership.
The UCLA Department of Surgery is committed to growing its endowed chair program. Philanthropic partnerships are key to this effort, enabling donors to make a lasting impact on surgical education and patient care. Expanding the number of endowed positions will ensure that UCLA continues to lead in surgical innovation, training and clinical excellence for generations to come.
Endowed Chairs Appointed in FY25

Vatche G. Agopian, MD Dumont-UCLA Chair of
Transplantation Surgery

Douglas G. Farmer, MD
Ronald W. Busuttil, MD, PhD and Sidney Kimmel Endowed Chair in Transplantation Surgery

Miklos Sahin-Toth, MD, PhD
Garry Shandling Chair in Pancreatic Diseases

Vincent L. Rowe, MD
Wiley F. Barker Endowed Chair in Vascular Surgery

Mediget Teshome, MD, MPH
Revlon
Join Us
If you are interested in partnering with us to sustain our vital work and expand our chair program, scan the QR code or visit us online at giving.ucla.edu/ surgeryreport25

For more information, please contact Jennifer Gray, senior director of development, jagray@mednet.ucla.edu

Chair in Women’s Health
FUTURE GOALS
Reaching Beyond the Summit
To deliver equitable, innovative and world-renowned surgical care illuminated by discovery and compassion
As we look ahead to the new academic year, we stand on a foundation built by years of shared effort, resilience and purpose. It is from this vantage point that I see a future full of promise, rooted in the values
that define us: excellence in care, leadership in education and a steadfast commitment to our community.
Stay rooted in our mission as academic surgeons
At UCLA, exceptional care goes hand in hand with exceptional teaching. As academic surgeons, we are called to provide outstanding clinical care while training the next generation of leaders in surgery. To do both, we must continue pushing the boundaries of clinical excellence through research. Advancing knowledge fuels better outcomes and ensures that our patients receive the most current, evidence-based treatments. By staying committed to innovation and discovery, we position ourselves to lead across the country and around the world.
Thrive together in a time of growth
Every person in our department demonstrates an unwavering commitment to our shared mission. There is no operation we cannot manage — and that kind of breadth and excellence is rare. As UCLA Health expands, with new medical centers and community clinics taking shape, we look forward to expanding our team and extending our reach to even more patients.
I believe in this department and the people who make it great. If we stay rooted in our values, support one another and keep our focus on the patients we serve, there is no summit we cannot reach together.

O. Joe
Hines,
MD Chair, Department of Surgery
